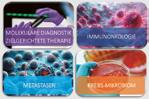
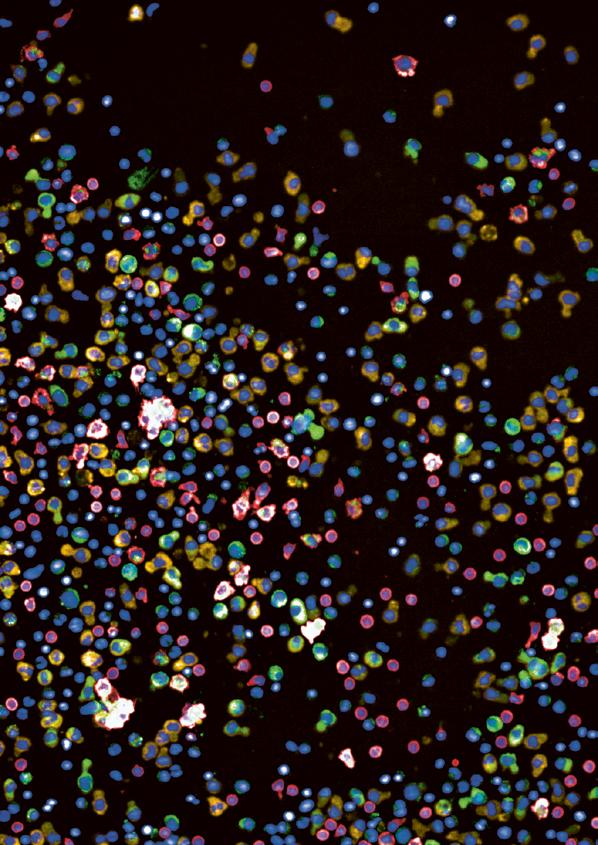

C OMPREHENSIVE
C ANCER C ENTER Z URICH
Das universitäre Zentrum für personalisierte Onkologie in der Schweiz




![]()
Das universitäre Zentrum für personalisierte Onkologie in der Schweiz




2022/2023
CCCZ – Ein gemeinsames onkologisches Exzellenzzentrum

Impressum
Herausgeber
Comprehensive Cancer Center Zürich (CCCZ) Rämistrasse 100 8091 Zürich www.usz.ch/cccz
Redaktion
Markus G. Manz, Prof. Dr. med. Maja Zenz, PhD
Gestaltung
Phil Klauser, info@klauserdesign.ch
Fotos Nicolas Zonvi
Druck
N&E Print, 8854 Siebnen
Auflage 500 Expl.
Stand August 2024

CCCZ
Up-date: Ida de Pottère Krebsforschungspreis
Up-date: CCCZ Cancer Survivors Day 2023
Up-date: Patient Engagement
Up-date: #SOLAgegenKrebs 2023
Up-date: Molekulares Tumorboard
Up-date: Präzisionsonkologie & Therapie
Up-date: Tagesklinikplattform
Up-date: Präzise Strahlentherapie
Up-date: Zielgerichtete Immuntherapie
Up-date: Hochspezialisierte Thoraxchirurgie
Up-date: Ein möglicher Patientenpfad
Up-date: DKG Zertifizierung
Wir freuen uns, Ihnen den ersten 2-Jahresbericht (2022/2023) des Comprehensive Cancer Center Zürich (CCCZ) vorzustellen. Mit diesem Bericht möchten wir einen Einblick in die Strukturen und Aktivitäten in den Bereichen Medizin, Forschung und Bildung in der Onkologie am Standort Zürich geben.
CCCZ: Geschichte und Gründung
Das CCCZ wurde im Jahr 2020 als ein gemeinsames onkologisches Exzellenzzentrum der Universität Zürich (UZH), des Universitätsspitals Zürich (USZ), der Universitätsklinik Balgrist und des Universitäts-Kinderspitals Zürich (KiSpi) gegründet. Die Entstehungsgeschichte des CCCZ geht aber bereits mehr als 10 Jahre zurück. Im Jahr 2011 begann das USZ mit der Zertifizierung der ersten Organzentren nach den Richtlinien der Deutschen Krebsgesellschaft (DKG). Schon ein Jahr später wurde das Tumorzentrum mit zehn Organzentren durch die DKG zertifiziert. In den Jahren 2017/2018 gründeten das USZ und die UZH das Klinische Krebszentrum (CCZ, USZ) und das Krebsforschungszentrum (CRC, UZH), um die Strategie in der Krebsmedizin und -forschung am Standort Zürich zu harmonisieren. Im Jahr 2020 wurden beide Zentren als CCCZ mit einer neuen Leitung zusammengeführt. Heute umfasst das CCCZ >20 klinische Abteilungen des USZ, KiSpi und Balgrist sowie >15 Institute der UZH mit >110 Mitgliedern, davon auch Mitglieder der Eidgenössischen Technischen Hochschule (ETHZ). Die erreichten Meilensteine des CCCZ in den Jahren 2022/2023 sind in Kapitel 6 dargestellt.
CCCZ: Mission
Unser Ziel ist es, die Behandlung und Versorgung von Krebspatient:innen zu verbessern. Dafür bietet das CCCZ eine ganzheitliche Krebsmedizin nach höchsten Standards, die auf die individuellen Bedürfnisse von an Krebs erkrankten Menschen zugeschnitten ist. Durch unsere Forschung können wir innovative und personalisierte Therapiekonzepte anwenden. Die Förderung der nächsten Generation talentierter Wissenschaftler:nnen, Ärzt:innen und onkologisch tätiger Fachpersonen in ihrer professionellen Entwicklung ist ebenso eine zentrale Aufgabe.
CCCZ: Kernbereiche
Sieben CCCZ Kernbereiche – Krebsforschung, Krebsmedizin, Klinische Studien, Blutund Gewebebanken, Technologien, Bioinformatik sowie Bildung & Outreach – steuern und treiben die strategische Entwicklung des CCCZ als onkologisches Exzellenzentrum am Standort Zürich. Lesen Sie mehr zu den Zielen und Leistungszahlen der CCCZ Kernbereiche in Kapitel 9.
CCCZ: Krebsforschung
Unser Forschungsschwerpunkt ist die Präzisionsonkologie. Dadurch bieten wir unseren Patient:innen einen Zugang zu personalisierten Behandlungskonzepten. Mediziner:innen und Wissenschaftler:innen aus rund 70 Forschungsgruppen arbeiten am CCCZ gemeinsam daran, die Entstehung und Entwicklung von Krebs besser
zu verstehen und neue Therapien zu entwickeln. Eine Schlüsselaufgabe besteht darin, eine kontinuierliche Verbindung von der Grundlagenforschung zu klinischen Studien zu schaffen. So können wissenschaftliche Entdeckungen effektiv in personalisierte Diagnoseverfahren und Therapien umgesetzt werden. Hervorheben mochten wir in Kapitel 10 die translationalen Forschungsnetzwerke der Zurich Research Community in den Bereichen molekulare Diagnostik und zielgerichtete Therapien, Immuntherapie, Mikrobiom und Metastasen.
CCCZ: Zusammenarbeit
Das CCCZ bildet eine interinstitutionelle und interdisziplinäre Plattform für innovative Krebsmedizin und Krebsforschung am Standort Zürich. Unser Ziel ist es, das onkologische Exzellenzzentrum weiterzuentwickeln und national sowie international an der Spitze zu positionieren. Möglich wird dies durch die einzigartige Zusammenarbeit von Menschen aus mehr als 50 Disziplinen und Fachbereichen. Wir alle setzen uns täglich in Diagnostik, Krankenversorgung, Forschung und Lehre dafür ein heute und in der Zukunft an Krebs erkrankten Menschen besser helfen zu können.
Wir wünschen viel Freude beim Lesen.
CCCZ Direktorium
Markus G. Manz, Prof. Dr. med. Chair CCCZ
Klinik für Medizinische Onkologie und Hämatologie, USZ/UZH
Andreas Wicki, Prof. Dr. med. Director CCCZ Clinical Program Klinik für Medizinische Onkologie und Hämatologie, USZ/UZH
Holger Moch, Prof. Dr. med. Director CCCZ Translational Research Programs Institut für Molekularpathologie und Pathologie, USZ/UZH
Bernd Bodenmiller, Prof. Dr. Director CCCZ Technologies Department of Quantitative Biomedicine, UZH/ETH
CCCZ Geschäftsstelle
Maja Zenz, PhD
Director Management Comprehensive Cancer Center Zürich, UZH
Matthias Guckenberger, Prof. Dr. med. Director CCCZ Outreach and Education Klinik für Radioonkologie, USZ/UZH
Konrad Basler, Prof. Dr. Director CCCZ Basic Research Institute for Molecular Life Sciences, UZH
Alexandre Theocharides, Prof. Dr. med. Director CCCZ Clinical Trials Program Klinik für Medizinische Onkologie und Hämatologie, USZ/UZH
Michael Krauthammer, Prof. Dr. med. Director CCCZ Bioinformatics Medizininformatik, USZ/UZH




Wir bieten Krebspatient:innen eine ganzheitliche und fachübergreifende Medizin auf höchstem Niveau.
Wir erforschen und entwickeln innovative Diagnostik- und Therapiekonzepte.
Wir informieren Krebsbetroffene und die Öffentlichkeit objektiv und transparent über Behandlungsoptionen und aktuelle Forschungsansätze.
Wir fördern die nächste Generation talentierter Wissenschaftler:innen, Ärzt:innen und onkologisch tätiger Fachpersonen in ihrer professionellen Entwicklung.
CCCZ: Medizinische Versorgung auf höchstem Niveau
Wir bieten fachübergreifende diagnostische und therapeutische Konzepte nach höchsten medizinischen Standards. Die aktuellen Forschungsergebnisse beziehen wir stets mit ein. Durch zahlreiche klinische Studien, die wir am CCCZ entwickeln und durchführen, können wir unseren Patient:innen neuartige Therapien anbieten.
CCCZ: Innovative Krebsforschung
Unser Ziel ist es, die Versorgung von Krebspatientinnen und Krebspatienten zu verbessern. Dazu entwickeln wir innovative Technologien und übertragen Erkenntnisse aus der Grundlagenforschung in die klinische Anwendung. Unser Forschungsschwerpunkt ist die Präzisionsonkologie. So ermöglichen wir unseren Patient:innen einen Zugang zu personalisierten Behandlungskonzepten.
CCCZ: Exzellente Bildung und Wissensvermittlung
Wir teilen unser Wissen und unsere Fähigkeiten im Bereich Krebsmedizin und Krebsforschung mit der nächsten Generation talentierter Wissenschaftler:innen, Ärtzt:innen und onkologisch tätigen Fachpersonen. Zusammen lernen wir kontinuierlich, wie wir die Betreuung unserer Patient:innen optimieren können. Wir informieren Krebsbetroffene transparent, und wir engagieren uns in der Gesellschaft rund um das Thema Krebs.
Das Comprehensive Cancer Center Zürich (CCCZ) ist ein gemeinsames onkologisches Exzellenzzentrum der Universität Zürich (UZH), des Universitätsspitals Zürich (USZ), der Universitätsklinik Balgrist und des Universitäts-Kinderspitals Zürich (KISPI). Am CCCZ werden innovative Krebsmedizin und Krebsforschung vereint. Wir stellen präzise Diagnosen und beraten stets persönlich und umfassend auf der Grundlage Evidenzbasierter Medizin. Durch unsere Forschung können wir innovative und personalisierte Behandlungskonzepte anwenden. Das CCCZ ermöglicht eine ganzheitliche medizinische Versorgung, die auf die individuellen Bedürfnisse von an Krebs erkrankten Menschen zugeschnitten ist.
The Comprehensive Cancer Center Zurich (CCCZ) is an oncology center of excellence of the University of Zurich (UZH), the University Hospital Zurich (USZ), the Balgrist University Hospital and the University Children’s Hospital Zurich. CCCZ strives for excellence in cancer research and cancer medicine. We use precise diagnostic technologies and offer personal consultation on the ground of evidence-based medicine. Our cancer research efforts are key to providing innovative and tailored treatments. CCCZ delivers comprehensive cancer care to the individual needs of all our patients.
CCCZ: Ziele
A: Exzellente Krebsmedizin nach den höchsten Standards
B: Innovative Krebsforschung für neue und personalisierte Behandlungskonzepte gegen Krebs
C: Exzellente Bildung und Wissensvermittlung für Mitarbeitende, Krebsbetroffene und die Gesellschaft
CCCZ: Aims
A: Excellent cancer medicine according to the highest standards
B: Innovative cancer research to develop standard-defining and personalized treatment concepts for patients
C: Excellent education and knowledge transfer for employees, patients and the general public
CCCZ: 5-Jahres Strategieplan
Übergeordnetes Ziel ist die strategische Weiterentwicklung des CCCZ als führendes Comprehensive Cancer Center für Präzisionsonkologie in Zürich, der Schweiz und Europa. Der Strategieplan für die Jahre 2022–2026 definiert die folgenden Kernbereiche und Ziele:
A: Exzellente Patientenversorgung: (1) Kontinuierliche Verbesserung der evidenzbasierten Patientenversorgung durch Forschung und Entwicklung, (2) Angebot innovativer und fachübergreifender diagnostischer und therapeutischer Konzepte nach höchsten medizinischen Standards und unter Einbezug der neusten Forschungs-
ergebnisse, (3) Etablierung eines Präzisionsonkologie-Programms für personalisierte Behandlungsansätze, (4) Entwicklung innovativer klinischer Studien und eines Studiennetzwerks Zürich.
B: Innovative Krebsforschung: (1) Verstärkter Ausbau interdisziplinärer Krebsforschungsprogramme in der Präzisionsonkologie, (2) Integration der Grundlagenforschung in translationale und klinische Konzepte, (3) Effiziente Aggregation und Auswertung von Forschungs- und klinischen Daten sowie Entwicklung von Bioinformatikinitiativen, (4) Konsolidierung der interdisziplinären ambulanten Patientenversorgung und translationalen/klinischen Forschung in einem zentralen CCCZGebäude.
C: Exzellente Ausbildung und Öffentlichkeitsarbeit: (1) Interdisziplinäre Ausbildung talentierter Wissenschaftler:innen und Ärzt:innen, (2) Talentförderung im Rahmen des CCCZ Felllow Program und des UZH Doktoratsprogramms, (3) transparente Information der Öffentlichkeit zum Thema «Krebs» und Patient Engagement, (4) Ausbau der Sichtbarkeit und Marke «CCCZ».
The overall aim is the strategic development of CCCZ as a leading Comprehensive Cancer Center for Precision Oncology in Zurich, Switzerland and Europe. The strategy plan specifies the following core areas and aims for the years 2022–2026:
A: Excellence in patient care: (1) continuously improve the standard of evidence-based care through research and development; (2) provide innovative and interdisciplinary diagnostic and therapeutic concepts according to the highest medical standards and incorporating the latest research results; (3) establish a CCCZ precision oncology program, providing access to personalized treatment concepts; (4) develop innovative clinical trials and a Zurich clinical trial network.
B: Innovative cancer research: (1) develop interdisciplinary cancer research programs in precision oncology; (2) integrate basic research into translational and clinical concepts; (3) efficiently aggregate and evaluate research and clinical data and develop bioinformatics initiatives; (4) merge multidisciplinary out-patient care and translational/clinical research in one core cancer center building.
C: Excellent training and public relations: (1) provide interdisciplinary training for scientists and physicians; (2) support talents within the frame of the CCCZ fellow program and the UZH PhD program “cancer biology”; (3) inform the general public and strengthen patient & public involvement; (4) expand the CCCZ visibility and brand. Image Film/Movie:
CCCZ: Leistungszahlen (Jahr 2023)
CCCZ: Key Numbers (Year 2023)



Krebsmedizin
17 spezialisierte Organzentren
2.119 Primärfälle (DKG)
4.253 aktiv behandelte Patient:innen
193 rekrutierende klinische Studien
267 Patient:innen in therapeutischen Studien (Phase I–III) behandelt
20 wöchentliche, interdisziplinäre Tumor Boards
15 supportive Beratungs- und Behandlungsdienste
>70 Forschungsgruppen
4 Forschungsschwerpunkte: Tumor Immunologie, (Epi)Genetik & Genomik, Onkogene Signalwege sowie Bildgebung, Technologieentwicklung & Digitalisierung
>600 Publikationen zum Thema Krebs von CCCZ Mitgliedern
229 aktive, extern begutachtete Krebsforschungsprojekte mit CHF
37.8 Mio. Drittmittelförderung (Jahr 2022)
>60 Weiterbildungsveranstaltungen mit >200 Sprechern
1 CCCZ-Fellow-Programm zur Förderung von talentierten Wissenschaftler:innen und forschenden Ärzt:innen
1 strukturiertes Weiterbildungsprogramm für Assistenzärzt:innen
112 Doktorand:innen & 11 Masterstudenten im PhD und Master Programm Cancer Biology der UZH
1 CCCZ Outreach-Programm, das Betroffene und die Öffentlichkeit informiert und mit einbezieht
Cancer Medicine
17 specialized organ centers
2.119 primary cases (DKG)
4.253 actively treated patients
193 recruiting clinical trials
267 patients enrolled in therapeutic trials (Phase I–III)
20 weekly, interdisciplinary tumor boards
15 supportive counseling and treatment services
Cancer research
>70 Research groups
4 focus research areas: Tumor Immunology, (Epi)Genetics & Genomics Oncogenic Signaling, and Imaging, Technology Development & Digitalization
>600 cancer-related publications from CCCZ members
229 active, cancer-related, peer-reviewed grants with CHF
37.8 Mio. third-party funding (year 2022)
>60 educational events with >200 speakers
1 CCCZ Fellow Program promoting talented scientists and clinician scientists
1 structured CCCZ curriculum for multidisciplinary oncology training for assistant physicians
112 PhD candidates & 11 master students in the PhD and master program Cancer Biology of UZH
1 CCCZ Outreach Program informing and engaging patients and the general public
Das CCCZ bündelt das Wissen von 4 starken Partnern
Universität Zürich (UZH): Mit rund 28.000 Studierenden ist die Universität Zürich die grösste und vielfältigste Universität der Schweiz. Sieben Fakultäten mit über 150 Instituten betreiben Forschung auf höchstem Niveau und bieten mehr als 200 Studienprogramme auf Bachelor-, Master- und Doktoratsstufe an. Als Mitglied der Hochschulallianzen League of European Research Universities (LERU), Una Europa und Universitas 21 (U21) gehört die UZH zum Kreis der führenden europäischen Universitäten.
Universitätsspital Zürich (USZ): Mit rund 900 Spitalbetten ist das USZ eines der grössten Spitäler der Schweiz. 2023 behandelte das USZ 39.153 stationären Patient:innen und verzeichnete 789.298 ambulante Besuche in seinen 42 Kliniken und Instituten.
9.697 Mitarbeitende aus 89 Ländern arbeiten am USZ, darunter 1.700 Ärzt:innen, 3.318 hochqualifizierte Pflegefachkräfte und 1.205 medizinisch-therapeutische und medizinisch-technische Mitarbeitende.
Universitäts-Kinderspital (KiSpi): Das KiSpi ist das grösste Zentrum für Pädiatrie und Kinderchirurgie in der Schweiz und eines der führenden Zentren weltweit. Es beschäftigt fast 2.600 Mitarbeitende, verfügt über rund 230 Betten und betreut jährlich knapp
8.500 stationäre und 90.000 ambulante Patient:innen.
Universitätsklinik Balgrist (Balgrist): Die Universitätsklinik Balgrist ist ein hochspezialisiertes Kompetenzzentrum für die Diagnose, Behandlung und Rehabilitation von Patient:innen mit Erkrankungen des Bewegungsapparates. Jährlich werden mehr als 6.700 Patient:innen im stationären Bereich behandelt und 121.000 ambulante Konsultationen durchgeführt. Am Balgrist arbeiten mehr als 1.200 Fachkräfte.
Die Onkologie ist ein Schwerpunktprogramm des USZ und der UZH. Im Jahr 2011 begann das USZ mit der Zertifizierung der ersten DKG-Organzentren. Schon ein Jahr später wurde das DKG-Tumorzentrum mit zehn Organzentren zertifiziert. In den Jahren 2017/2018 gründeten das USZ und die UZH das Klinische Krebszentrum (CCZ, USZ) und das Krebsforschungszentrum (CRC, UZH) mit gemeinsamen Vorstandssitzungen, um die Strategien in der Krebsmedizin und -forschung am Standort Zürich zu harmonisieren. Im Jahr 2020 wurden beide Zentren als CCCZ mit einer gemeinsamen Leitung zusammengeführt. Heute umfasst das CCCZ >20 klinische Abteilungen des USZ, des KiSpi und der Universitätsklinik Balgrist sowie >15 Institute der UZH mit >100 Mitgliedern, davon auch Mitglieder der ETHZ.

Die Gremien und Mitglieder des CCCZ sind verantwortlich für die strategische Entwicklung und den Betrieb des CCCZ als onkologisches Exzellenzzentrum am Standort Zürich zum Wohle der Patient:innen sowie der Gesellschaft.
CCCZ Kuratorium




Beatrice Beck Schimmer, Prof. Dr. med., Direktorin Universitäre Medizin Zürich, UZH, Chair CCCZ Kuratorium
Gabriela Senti, Prof. Dr. med., Direktorin Forschung und Lehre, USZ
Michael Grotzer, Prof. Dr. med., Medizinischer Direktor, Universitätskinderspital Zürich
Markus G. Manz, Prof. Dr. med., Chair CCCZ (Beisitz)
CCCZ Direktorium



CMarkus Manz, Prof. Dr. med. – Chair CCCZ Klinikdirektor Medizinische Onkologie und Hämatologie, USZ/UZH
Andreas Wicki, Prof. Dr. med. – Director CCCZ Clinical Program, Stellvertr. Klinikdirektor, Medizinische Onkologie und Hämatologie, USZ/UZH
Konrad Basler, Prof. Dr. rer. nat. – Director CCCZ Basic Research Forschungsgruppenleiter, Institute for Molecular Life Sciences, UZH
CCCCZ Direktorium





CHolger Moch, Prof. Dr. med. – Director CCCZ Translational Research Programs Direktor Institut für Molekularpathologie und Pathologie, USZ/UZH
Alexandre Theocharides, Prof. Dr. med. – Director CCCZ Clinical Trials Program Leitender Arzt, Medizinische Onkologie und Hämatologie, USZ/UZH
Bernd Bodenmiller, Prof. Dr. rer. nat. – Director CCCZ Technologies Director Department of Quantitative Biomedicine, UZH/ETH
Michael Krauthammer, Prof. Dr. med. – Director CCCZ Bioinformatics Direktor Medizininformatik, USZ/UZH
Matthias Guckenberger, Prof. Dr. med. – Director CCCZ Outreach and Education Klinikdirektor, Radioonkologie, USZ/UZH
CCCZ Geschäftsstelle

Maja Zenz, PhD – Director Management CCCZ, UZH
CCCZ Clinical Program
Die Organisation des CCCZ Clinical Program (CP) wird durch das Leitungsgremium, den Vorstand und das Tumordokumentationsteam sichergestellt. Das CP Leitungsgremium ist zuständig für die Definition und Umsetzung der Ziele des Clinical Program und unterstützt die Organzentren bei der Erfüllung ihrer Aufgaben. Der CP Vorstand setzt sich zusammen aus dem CP Leitungsgremium, den Organzentrenleiter:innen und Vertreter:innen der onkologischer Querschnittsfächer. Er ist zuständig für die Definition und Evaluation der Ziele der Organzentren und den Entscheid über den Aufbau von weiteren Organzentren. Das CP Tumordokumentationsteam unterstützt das Qualitäts- und Datenmanagement der Organzentren.
CP Leitungsgremium
Andreas Wicki, Prof. Dr. med. – Director CCCZ Clinical Program
Anna Götz, PhD – CCCZ Pflegeexpertin
Silke Schneider, Dr. rer. nat. – CCCZ CP Team and Project Manager
CP Tumordokumentationsteam
Anka Baltensperger, Isabel Breyer, Soeren Geisler, Marc Scherrer, Valentine Marcar, Franziska Walser, Laura Niggli, Eleonora Esser
Wissenschaftlicher Beirat/Scientific Advisory Board des CCCZ
Der wissenschaftliche Beirat des CCCZ setzt sich aus führenden, internationalen Expert:innen in der Krebsmedizin und -forschung zusammen. Er begleitet und berät das CCCZ in organisatorischen und inhaltlichen Entscheidungen für die strategische Entwicklung des CCCZ als onkologisches Exzellenzzentrum.
Mitglieder/Members
Sir Prof. Alex Markham, Professor of Medicine in Leeds and former Chief Executive of Cancer Research UK, UK (SAB chair)
Prof. Angelika Eggert, Director Department of Pediatric Oncology and Hematology, Charite, Berlin, Germany
Prof. Margaret Frame, Professor of Cancer Research, Director: Institute of Genetics and Cancer, Cancer Center Edinburgh, UK
Prof. Stefan Fröhling, Director Translational Oncology, National Center for Tumor Diseases, Heidelberg, Germany
Prof. Yolande Lievens, Chair of Department, Radiation Oncology, CRIG, Gent University, Belgium
Prof. Andreas Mackensen, Director Hematology and Medical Oncology, University Hospital Erlangen, Germany
Prof. Kjetil Tasken, Director Institute of Cancer Research (ICR), Professor Oslo Univ. Hospital (OUH), Norway

«The CCCZ Precision Oncology Programs are very impressive, highly clinically relevant, delivering science of the very highest international quality and show how powerful the academic interaction at the Zurich hub can be… there is huge potential and talent in Zurich in basic, translational and clinical cancer research.»
Sir Alex Markham
Professor of Medicine in Leeds and former Chief Executive of Cancer Research UK, Chair CCCZ SAB
UP-DATE
Der externe, wissenschaftliche Beirat bewertet das CCCZ als onkologisches Spitzenzentrum
Am 2.–3.10.2023 tagte der wissenschaftliche Beirat des CCCZ zum ersten Mal in Zürich im altehrwürdigen Senatszimmer an der Universität Zürich. Derzeit gibt es in der Schweiz kein Exzellenz- und Zertifizierungsprogramm für Comprehensive Cancer Centers (CCC). Dies bedeutet, dass es in der Schweiz keine offiziell definierten Standards für interdisziplinäre, moderne Krebszentren gibt, die sich auf die Entwicklung neuer Ansätze zur Prävention, Diagnose und Behandlung von Krebs spezialisieren. Aufgrund der Vergleichbarkeit der Gesundheitssysteme in Deutschland und der Schweiz hat das CCCZ Direktorium seinen Beirat gebeten, das CCCZ nach den strengen Kriterien des Zertifizierungsprogramms «Onkologische Spitzenzentren» der Deutschen Krebshilfe (DKH) zu evaluieren. Auf Basis eines 130-seitigen Statusberichts sowie über 30 Vorträgen von Ärzt;innen und Wissenschaftler:innen des CCCZ kam der wissenschaftliche Beirat zu folgendem zusammenfassendem Evaluierungsbeschluss: Die interdisziplinäre Organisation der Patientenversorgung und innovative Krebsforschungsprogramme des CCCZ erfüllen die Standards eines onkologischen Exzellenzzentrums nach internationalen Kriterien.

«Der kritisch-konstruktive Blick auf das CCCZ von aussen durch internationale Experten ist für uns essentiell. Die Bewertung nach international anerkannten Kriterien zeigt uns zum einen, dass wir auf dem richtigen Weg sind, am Standort Zürich ein Spitzenzentrum für Krebsmedizin und -forschung zu entwickeln. Zum anderen erhalten wir wertvolle Impulse für notwendige strukturelle und inhaltliche Verbesserungsmöglichkeiten.»
Markus G. Manz, Prof. Dr. med. Chair CCCZ
CCCZ Strategy Workshops
Das CCCZ Direktorium veranstaltet jährlich Strategy Workshops mit Vertreter:innen aus den CCCZ Kernbereichen, Organzentren und Forschungsgruppen. Die Workshops geben einen gesamthaften Überblick über aktuelle Aktivitäten und Entwicklungen, ermöglichen einen interaktiven Austausch zwischen den Disziplinen und sind damit wichtige Treiber für die Struktur- und Exzellenzbildung am CCCZ. Jedes Jahr werden ausgewählte Themen aus den Bereichen Krebsmedizin, Forschung und Lehre in den Fokus gestellt. Die gewonnenen Erkenntnisse aus den interdisziplinären Diskussionen der CCCZ Mitglieder und Stakeholder und die daraus abgeleiteten Implementierungsmassnahmen sind essentiell für die weitere strategische Entwicklung des CCCZ als onkologisches Exzellenzzentrum. Der Workshop am 3.–4.7.2023 in der Karthause Ittingen wurde durch Prof. Dr. Tim Brümmendorf als externer Gutachter begleitet.
UP-DATE C OMPREHENSIVE

«Es gibt am CCCZ beeindruckende Forschung, sichtbare Leuchttürme und überzeugende Beispiele für klinisch-translationale Exzellenz.
Für die weitere strategische Entwicklung des CCCZ als international kompetitives, onkologisches Exzellenzzentrum/CCC kommt den dezidierten und seit 2022 erfreulicherweise intramural geförderten CCCZ Leuchtturmprojekten eine herausragende Bedeutung zu.»
Tim H. Brümmendorf, Prof. Dr. med. Leitung des CIO Aachen, Direktor Klinik für Hämatologie und Onkologie Universitätsklinikum Aachen
ANCER C ENTER
Das universitäre Zentrum für personalisierte Onkologie in der Schweiz
CCCZ Steering Committee

Director UMZH
Beatrice Beck Schimmer (SC chair)

Director Research and Education USZ
Gabriela Senti

Delegate KiSpi (in rotation with Balgrist) Michael Grotzer

Chair CCCZ
Markus G. Manz (Beisitz)
CCCZ Executive Committee


Director Management Maja Zenz

Director Clinical Program Andreas Wicki

Chair Markus G. Manz
Director Clinical Trials Alexandre Theocharides

Director Outreach and Education
Matthias Guckenberger

Director Technologies
Bernd Bodenmiller

Director Basic Research Konrad Basler

Director Translational Research Programs Holger Moch

Director Bioinformatics Michael Krauthammer
>110 CCCZ members from UZH, USZ, Balgrist, KiSpi and ETH Zurich
CCCZ Scientific Advisory Board
Sir Alex Markham, Professor of Medicine in Leeds and former Chief Executive of Cancer Research UK, UK (SAB chair); Kjetil Tasken, Director Institute of Cancer Research (ICR), Professor Oslo Univ. Hospital (OUH), Norway; Yolande Lievens, Chair Department Radiation Oncology, CRIG, Gent University, Belgium; Margaret Frame, Professor of Cancer Research, Director Institute of Genetics and Cancer, Cancer Center Edinburgh, UK; Stefan Fröhling, Director Translational Oncology, National Center for Tumor Diseases, Heidelberg, Germany; Andreas Mackensen, Director Hematology and Medicial Oncology, University Hospital Erlangen, Germany; Angelika Eggert, Director Department of Paedriatric Oncology and Hematology, Charite, Berlin, Germany






Blasen- und Nierentumorzentrum/ Bladder and Kidney Cancer Center
Prof. Dr. med. Anja Lorch, MOH
Prof. Dr. med. Matthias Guckenberger, RAO
PD Dr. med. Manuela Hunziker, URO
PD Dr. med. Michael Christian Mayinger, URO
Dr. med. Tomas Brezina, MOH
Prof. Dr. med. Daniel Eberli, URO
Brustzentrum/ Breast Cancer Center
Prof. Dr. med. Isabelle Witzel, GYN
Prof. Dr. med. Bernhard Pestalozzi, MOH
Dr. med. Heike Frauchinger-Heuer, GYN
Prof. med. Dr. Zsuzsanna Varga, PATH


Darmtumorzentrum/ Colorectal Cancer Center
PD Dr. med. Ralph Fritsch, MOH
Dr. med. Claudia Linsenmeier, RAO
Prof. Dr. med. Matthias Turina, VIS
Prof. Dr. med. Daniel Pohl, GAE

Endokrines und Neuroendokrines Tumorzentrum/NET Center
PD Dr. med. Ralph Fritsch, MOH
Prof. Dr. med. Jose Oberholzer, VIS
Prof. Dr. med. Svenja Nölting, END

Gynäkologisches Tumorzentrum/ Gynecologic Oncology Center
Prof. Dr. med. Isabelle Witzel, GYN
Dr. med. Eleftherios Pierre Samartzis, GYN
Prof. Dr. med. Bernhard Pestalozzi, MOH
Dr. med. Claudia Linsenmeier, RAO
Robert Grabolus, GYN

Hauttumorzentrum/ Skin Cancer Center
Prof. Dr. med. Reinhard Dummer, DER
PD Dr. med. Johanna Mangana, DER
Dr. med. Dr. sc. nat. Barbara Meier Schiesser, DER
Dr. med. Dr. sc. nat. Egle Ramelyte, DER
Prof. Dr. med. Jürg Hafner, DER

Hirntumorzentrum/ Brain Tumor Center
Prof. Dr. med. Michael Weller, NEU
Prof. Dr. med. Luca Regli, NCH
Prof. Dr. med. Patrick Roth, NEU
PD Dr. med. Carlo Serra, NCH
Hoden- und Penistumorzentrum/ Testicular and Penile Tumor Center
Prof. Dr. med. Anja Lorch, MOH
Prof. Dr. med. Matthias Guckenberger, RAO
PD Dr. med. Michael Christian Mayinger, URO
Dr. med. Tomas Brezina, MOH
Prof. Dr. med. Daniel Eberli, URO
Dr. med. John Ethan Rampa, URO
Kopf-Hals-Tumorzentrum/ Head and Neck Cancer Center
Dr. med. Simon Müller, ORL
Prof. Dr. med. Panagiotis Balermpas, RAO
Dr. med. Tomas Brezina, MOH
Dr. med. Dr. med. dent. Elisabeth Goetze, MKG
PD Dr. med. Gregoire Morand, ORL
Leber- und Pankreastumorzentrum/ Liver and Pancreatic Cancer Center
Prof. Dr. med. Henrik Petrowsky, VIS
PD Dr. med. Ralph Fritsch, MOH
Lungen- und Thoraxonkologiezentrum/ Lung and Thoracic Oncology Center
Prof. Dr. med. Isabelle Schmitt-Opitz, THO
Prof. Dr. med. Matthias Guckenberger, RAO
Dr. med. Carolin Steinack, PNE
Prof. Dr. med. Dr. rer. nat. Andreas Wicki, MOH
Dr. med. Ulrich Richter, MOH
Magen- und Ösophagustumorzentrum/ Esophageal and Gastric Cancer Center
Prof. Dr. med. Christian Gutschow, VIS
PD Dr. med. Ralph Fritsch, MOH





Prostatakarzinomzentrum/ Prostate Cancer Center
Prof. Dr. med. Anja Lorch, MOH
Prof. Dr. med. Matthias Guckenberger, RAO
Dr. med. Dr. sc. Med. Florian Schmid, URO
PD Dr. med. Michael Christian Mayinger, URO
Dr. med. Tomas Brezina, MOH
Prof. Dr. med. Daniel Eberli, URO
Sarkomzentrum/Sarcoma Center
PD Dr. med. Daniel Müller, Balgrist
Dr. med. Lorenz Bankel, MOH
Dr. med. Dominik Kaiser, Balgrist
Prof. Dr. med. Jana Ellegast, MOH
Dr. med. PhD Willemijn Breunis, KISPI
PD Dr. med. Sören Könneker, PCH
Dr. med. Michelle Leanne Brown, RAO
Schilddrüsentumorzentrum/ Thyroid Cancer Center
Prof. Dr. med. Jan Krützfeldt, END
Dr. med. AnjIvette Engel-Bicik, NUK
PD Dr. med. Diana Vetter, VIS
Zentrum für Hämatologische Neoplasien/ Center for Hematologic Malignancies
Prof. Dr. med. Markus Manz, MOH
Prof. Dr. med. Thorsten Zenz, MOH
Dr. med. Wiebke Rösler, MOH
Dr. med. Rouven Müller, MOH
Zentrum für Onkologie Universitäts-Kinderspital Zürich/ Center for Pediatric Oncology
Prof. Dr. med. Jean-Pierre Bourquin, KISPI
Dr. med. Eveline Stutz, KISPI
Dr. sc. nat. Claudia Althaus, KISPI
Balgrist – Universitätsklinik Balgrist; DER – Klinik für Dermatologie; END – Klinik für Endokrinologie, Diabetologie und Klinische Ernährung; GAE – Klinik für Gastroenterologie und Hepatologie; GYN – Klinik für Gynäkologie; KISPI – UniversitätsKinderspital; MOH – Klinik für Medizinische Onkologie und Hämatologie; MKG – Klinik für Mund-, Kiefer- und Gesichtschirurgie; NCH – Klinik für Neurochirurgie; NEU – Klinik für Neurologie; NUK – Klinik für Nuklearmedizin; ORL – Klinik für Ohren-, Nasen-, Hals- und Gesichtschirurgie; PATH – Institut für Pathologie und Molekularpathologie; PCH – Klinik für plastische Chirurgie und Handchirurgie; PNE – Klinik für Pneumologie; RAO – Klinik für Radioonkologie; THO – Klinik für Thoraxchirurgie; URO – Klinik für Urologie; VIS – Klinik für Viszeral- und Transplantationschirurgie
Forschungsgruppen/Research Groups (Stand Juli 2024)

Prof. Dr. Isabelle Arnold
Inst. of Experimental Immunology, UZH
Prof. Dr. Burkhard Becher
Inst. of Experimental Immunology, UZH
Prof. Dr. Bernd Bodenmiller
Dep. of Quantitative Biomedicine, UZH
Prof. Dr. Lubor Borsig
Inst. of Physiology, UZH
Prof. Dr. Onur Boyman
Dep. of Immunology, USZ
Prof. Dr. Richard Chawan
Inst. of Experimental Immunology, UZH
Prof. Dr. Reinhard Dummer
Dep. of Dermatology, USZ
Prof. Dr. Jana Ellegast
Dep. of Medical Oncology and Hematology, USZ
Prof. Dr. Melanie Greter
Inst. of Experimental Immunology, UZH
Prof. Dr. Kuno Lehmann
Dep. of Visceral- und Transplantation Surgery, USZ
Prof. Dr. Chiara Magnani
Dep. of Medical Oncology and Hematology, USZ
Prof. Dr. Markus Manz
Dep. of Medical Oncology and Hematology, USZ
Prof. Dr. Christian Münz
Inst. of Experimental Immunology, UZH
Prof. Dr. Cesar Nombela-Arrieta
Dep. of Medical Oncology and Hematology, USZ
Prof. Dr. Patrick Roth
Dep. of Neurology, USZ
Prof. Dr. Dominik Schneidawind
Dep. of Medical Oncology and Hematology, USZ
Prof. Dr. Michael Scharl
Dep. of Gastroenterology and Hepatology, USZ
Prof. Dr. Christian Stockmann
Inst. of Anatomy, UZH
Prof. Dr. Sonia Tugues
Inst. of Experimental Immunology, UZH
Prof. Dr. Maries van den Broek
Inst. of Experimental Immunology, UZH
Prof. Dr. Michael Weller
Dep. of Neurology, USZ

EPIGENETICS, GENETICS & GENOMICS
Prof. Dr. Matthias Altmeyer
Dep. of Mol. Mechanisms of Disease, UZH
Prof. Dr. Felix Beuschlein
Dep. of Endocrinology, Diabetology and Clinical Nutrition, USZ
Prof. Dr. Jacob Corn
Dep. of Biology, ETH
Prof. Dr. Pavel Janscak
Inst. of Molecular Cancer Research, UZH
Prof. Dr. Mitch Levesque
Dep. of Dermatology, USZ
Prof. Dr. Massimo Lopes Inst. of Molecular Cancer Research, UZH
Prof. Dr. Giancarlo Marra
Inst. of Molecular Cancer Research, UZH
Prof. Dr. Holger Moch
Inst. for Pathology and Molecular Pathology, USZ
Prof. Dr. Anne Müller Inst. of Molecular Cancer Research, UZH
Prof. Dr. Hanspeter Nägeli Inst. of Veterinary Pharmacology and Toxicology, UZH
Prof. Dr. Chantal Pauli
Inst. for Pathology and Molecular Pathology, USZ
Prof. Dr. Lorenza Penengo Inst. of Molecular Cancer Research, UZH
Prof. Dr. Gerhard Rogler
Dep. of Gastroenterology & Hepatology, USZ
Prof. Dr. Raffaella Santoro
Dep. of Mol. Mechanisms of Disease, UZH
Prof. Dr. Alessandro Sartori Inst. of Molecular Cancer Research, UZH
Prof. Dr. Beat Schäfer University Childrens’ Hospital
Prof. Dr. Gerald Schwank Inst. of Pharmacology & Toxicology, UZH
Prof. Dr. Manuel Stucki
Dep. of Gynecology, USZ
Prof. Dr. Didier Surdez Balgrist University Hospital

ONCOGENIC SIGNALING
Prof. Dr. Konrad Basler
Inst. of Molecular Life Sciences, UZH
Prof. Dr. Martin Baumgartner University Childrens’ Hospital
Prof. Dr. Beat Bornhauser University Childrens’ Hospital
Prof. Dr. Jean-Pierre Bourquin University Childrens’ Hospital
Prof. Dr. Raghvendra Dubey
Dep. of Reproduct. Endocrinology, USZ
PD Dr. Ralph Fritsch
Dep. of Medical Oncology and Hematology, USZ
Prof. Dr. Alex Hajnal
Inst. of Molecular Life Sciences, UZH
Prof. Dr. Jason Holland Department of Chemistry, UZH
Prof. Dr. Michael Hottiger
Dep. of Molecular Mechanisms of Disease, UZH
PD Dr. Emilie Le Rhun
Dep. of Medical Oncology and Hematology, USZ
Prof. Dr. Martin Pruschy
Dep. of Radiation Oncology, USZ
Prof. Dr. Isabelle Schmitt-Opitz
Dep. of Thoracic Surgery, USZ
Prof. Dr. Lukas Sommer
Inst. of Anatomy, UZH
Prof. Dr. Alexandre Theocharides
Dep. of Medical Oncology and Hematology, USZ
Prof. Dr. Achim Weber
Inst. for Pathology and Mol. Pathology, USZ
Prof. Dr. Sabine Werner
Inst. for Molecular Health Sciences, ETH
Prof. Dr. Andreas Wicki
Dep. of Medical Oncology and Hematology, USZ
Prof. Dr. Lynn Wong
Inst. of Experimental Immunology, UZH
Prof. Dr. Thorsten Zenz
Dep. of Medical Oncology and Hematology, USZ

IMAGING, TECHNOLOGY DEVELOPMENT & DIGITALISATION
Prof. Dr. Panagiotis Balermpas Dep. of Radiation Oncology, USZ
Prof. Dr. Amedeo Caflisch
Dep. of Biochemistry, UZH
Prof. Dr. Daniel Eberli Dep. of Urology, USZ
Prof. Dr. Thomas Frauenfelder Inst. of Radiology, USZ
Prof. Dr. Urs Greber Inst. of Molecular Life Sciences, UZH
Prof. Dr. Matthias Guckenberger Dep. of Radiation Oncology, USZ
Prof. Dr. Michael Krauthammer Biomedical Informatics, USZ
PD Dr. Thomas Gaisl Dep. of Pulmonology, USZ
PD Dr. Michael Mayinger Dep. of Radiation Oncology, USZ
Prof. Dr. Andreas Plückthun Dep. of Biochemistry, UZH
Prof. Dr. Gunnar Rätsch Dep. of Computer Science, ETH
Prof. Dr. Luca Regli Dep. of Neurosurgery, USZ
Prof. Dr. Roger Schibli Dep. of Chemistry and Applied Biosciences, ETH
Prof. Dr. Berend Snijder Inst. of Molecular Systems Biology, ETH Zürich
Dr. Carolin Steinack Dep. of Pulmonology, USZ


Das CCCZ wird von der UZH/UMZH mit CHF 10 Mio. für die Jahre 2022–2026 finanziert (siehe Abbildung). Die Gelder unterstützen vier Leuchtturmprojekte, das Programm für Klinische Studien, das Tumorprobenverarbeitungslabor, das Bioinformatik Programm, das «Cancer Biology» Doktoratsprogramm der UZH sowie die Geschäftsstelle des CCCZ. Das USZ finanziert die Leitung des CCCZ Clinical Program, das klinische Datenmanagement sowie das spezialisierte Pflegemanagement des CCCZ mit CHF 1.4 Mio. pro Jahr.
Finanzierung von CCCZ Kernaktivitäten und Präzisionsonkologieprogrammen durch die UMZH/UZH (2022–2026) und USZ (p.a.)

CHF 5.8 Mio
UMZH/UZH
CCCZ
Förderprogramm für Präzisionsonkologie
CCCZ
Leuchtturmprojekt Cancer Microbiome
CCCZ
Leuchtturmprojekt PROMIS
CCCZ
Leuchtturmprojekt ZURICAR
CCCZ
Leuchtturmprojekt OMD-ZH
CHF 3.24 Mio
UMZH/UZH
CCCZ
Präzisionsonkologie Programm
Programm für Klinische Studie
TumorprobenVerarbeitungslabor
Bioinformatik Programm
CHF 1.4 Mio USZ
CCCZ Klinisches Programm
Management Datenmanagement Pflegemanagement
CHF 960 K UMZH/UZH
CCCZ Geschäftsstelle
Management PhD Programm Outreach
Am Standort Zürich vereint die Universitäre Medizin Zürich (UMZH) in ihrem Netzwerk die renommierten Zürcher Hochschulen und universitären Spitäler: Universität Zürich, ETH Zürich, Universitätsspital Zürich, Universitäts-Kinderspital Zürich, Universitätsklinik Balgrist und Psychiatrische Universitätsklinik Zürich. Die UMZH fördert die Zusammenarbeit in den Bereichen Forschung, Lehre und Patientenversorgung. Im Mittelpunkt stehen Patient:innen sowie die Gesundheit der Bevölkerung. Dabei entwickelt die UMZH Strategien, damit Erkenntnisse aus der Grundlagenforschung konsequent in die Klinik umgesetzt werden und Anregungen aus der Versorgung in die Forschung zurückgehen (bi-direktionale Translation). Wissenschaftlicher Schwerpunkt ist die Präzisionsmedizin mit dem Ziel, personalisierte Prävention, Diagnostik und Therapien zu entwickeln. Dazu werden gesundheitsrelevante Daten in der sich im Aufbau befindlichen Biomedizininformatik-Plattform für die Forschung inklusive der vernetzten Anwendung von Künstlicher Intelligenz nutzbar gemacht. Schwerpunktmässig unterstützte und geförderte Forschungszentren der UMZH sind The LOOP Zurich, das Tumor Profiler Center und das CCCZ.

«Die UMZH setzt einen ersten Schwerpunkt auf die Präzisionsmedizin und möchte mit der Förderung des CCCZ die Onkologie am Standort Zürich weiter stärken.»
Beatrice Beck Schimmer, Prof. Dr. med. Direktorin UMZH, Chair CCCZ Kuratorium
Das CCCZ integriert >110 Mitglieder aus >20 klinisch-universitären Abteilungen des USZ, KiSpi und Balgrist sowie >15 akademischen Instituten/Departments der UZH und ETH. Der interdisziplinäre Wissensaustausch schafft Synergien in der Patientenversorgung und ermöglicht fachübergreifende Kooperationen. Hervorzuheben ist die aktive Beteiligung und Leitung des CCCZ an zahlreichen Forschungsverbundprojekten der Zurich Cancer Research Community (siehe Kapitel 10).

«Durch das synergistische Zusammen von translationaler Forschung und Klinik und von Kinder- und ErwachsenenOnkologie gelingt es uns, die Behandlung von Patient:innen mit Krebserkrankungen weiter zu verbessern.»
Michael Grotzer, Prof. Dr. med. Medizinische Direktor KISPI, Mitglied CCCZ Kuratorium

«Die Onkologie ist ein wichtiger Versorgungschwerpunkt am USZ. Das CCCZ leistet einen enormen Beitrag dazu.
Ärzt:innen, Forschende und Pflegende arbeiten Hand in Hand, um den Patient:innen innovative Therapien und eine gute Lebensqualität zu ermöglichen.»
Gabriela Senti, Prof. Dr. med. Direktorin Forschung und Lehre, USZ, Mitglied CCCZ Kuratorium
Regional steht das CCCZ steht in engem Austausch mit zahlreichen niedergelassenen Onkologen und Spitälern:
– Langjährige Kooperationen bestehen unter anderen mit dem: Kantonsspital Aarau, Luzerner Kantonsspital, Kantonsspital St. Gallen, Spital Männedorf, Kantonsspital Winterthur, Spital Uster, Spital Wetzikon, Kantonsspital Baden und Stadtspital Zürich (Triemli, Waid). Die Zusammenarbeit umfasst die Bereiche komplexe Diagnostik, gemeinsame Patientenbetreuung, molekulare Präzisionsonkologie, zelluläre Therapien und die CCCZ Tumorboards. Hervorzuheben ist die Zusammenarbeit mit dem Spital Männedorf bei Brustkrebs, mit dem Spital Wetzikon bei uroonkologischen Tumoren, mit den Spitälern Wetzikon und Uster bei hämatoonkologischen Erkrankungen und mit dem Stadtspital Zürich Triemli bei hämatopoetischen Stammzelltransplantationen.
– Im Bereich der psychoonkologischen Betreuung von ambulanten Patient:innen kooperiert das CCCZ eng mit den kantonalen Krebsligen.
– Über sein Outreach & Education Programm bietet das CCCZ Fortbildungsmöglichkeiten für externe Kolleg:innen im Bereich der Onkologie (siehe Kapitel 9.1).
Auf (inter)nationaler Ebene arbeitet das CCCZ mit der Schweizerischen Arbeitsgemeinschaft für Klinische Krebsforschung (SAKK) und dem Swiss Personalized Health Network (SPHN) zusammen. Das CCCZ bietet einen Zweitmeinungsdienst für in der Schweiz krankenversicherte Patient:innen an. Ausländische Patient:innen können sich für eine Zweitmeinung an das internationale Büro des USZ wenden. Das CCCZ kooperiert darüber hinaus mit zahlreichen Organisationen, Gesellschaften und Instituten im In- und Ausland.
CCCZ Zweitmeinungsportal: www.usz.ch/cccz-zweitmeinung

Sieben Kernbereiche – Krebsforschung, Krebsmedizin, Klinische Studien, Blut- und Gewebebanken, Technologien, Bioinformatik und Bildung & Outreach – steuern und treiben die strategische Entwicklung des CCCZ als onkologisches Exzellenzentrum am Standort Zürich. Ziel ist es, innovative klinische Onkologie, Forschung und Technologien zu verbinden, um neue diagnostische und therapeutische Konzepte in der Präzisionsonkologie zu entwickeln.

Wir teilen unser Wissen in der Krebsmedizin und -forschung Wir bilden die nächste Generation talentierter Wissenschaftler:innen, Ärzt:innen und onkologisch tätiger Fachpersonen aus. Zusammen lernen wir kontinuierlich, wie wir die Betreuung unserer Patient:innen weiter verbessern können. Wir informieren und engagieren die Gesellschaft rund um das Thema Krebs. Durch den Austausch mit Selbsthilfegruppen und Patientenorganisationen möchten wir die Perspektive von Krebsbetroffenen besser verstehen und in Entscheidungen und Prozesse des CCCZ integrieren.
>60 jährliche Seminare und Symposien im Bereich Onkologie mit >200 Vortragenden
112 Doktorierende und 11 Masterstudierende pro Jahr im Doktoratsprogramm und im Masterstudiengang Krebsbiologie der UZH
1 kompetitives Förderprogramm (CCCZ Fellow Program) fördert die nächste Generation von herausragenden Wissenschaftler:innen und forschenden Ärzt:innen in der translationalen
Onkologie
1 strukturiertes CCCZ-Curriculum ermöglicht eine multidisziplinäre onkologische Ausbildung von Assistenzärzt:innen
1 jährlicher Cancer Survivors Day und 6 Patient Academies, welche Betroffene und die Gesellschaft rund um das Thema Krebs informieren und engagieren
1 Patientenbeirat lässt die Sichtweise von Patient:innen und Angehörigen in die Planung und Durchführung von Prozessen und Entscheidungen am CCCZ einfliessen

«Das CCCZ Outreach & Education Program erfüllt eine der wichtigsten Aufgaben des CCCZ: Die nächste Generation talentierter Wissenschaftler:innen, Ärzt:innen und onkologisch tätiger Fachpersonen in ihrer professionellen Entwicklung zu unterstützen und fördern.»
Matthias Guckenberger, Prof. Dr. med. CCCZ Director Outreach and Education

«Mit meiner Arbeit kann ich die Bereiche Medizin und Forschung zusammenbringen, was Patient:innen zugutekommt.
Besonders schön ist es, Patient:innen an unseren Patient Academies und am Cancer Survivors Day persönlich kennenzulernen und auch über die Jahre immer wiederzutreffen.»
Silke Uflacker CCCZ Event Manager
Für Ärzt:innen und Wissenschaftler:innen www.usz.ch/c3z-veranstaltungen-aerzte
Für Patient:innen und Betroffene www.usz.ch/cccz-patientenveranstaltungen
UP-DATE
Das CCCZ Fellow Programm fördert die Aus- und Weiterbildung der nächsten Generation von herausragenden Talenten in der Onkologie. Das Programm vergibt in einem kompetitiven, extern begutachteten Auswahlverfahren 2-jährige Stipendien. Gefördert werden Nachwuchswissenschaftler:innen sowie forschenden Ärzt:innen (clinician scientists), die durch die Durchführung eines 2-jährigen interdisziplinären Projekts an der UZH und den universitären Spitälern eine Brücke zwischen Grundlagen- und klinischer Forschung schlagen.
Das Programm integriert die Fellows in die Labors, Meetings und die Kommunikation der Zürcher Krebsforschungsgemeinschaft und bietet eine Umgebung, in der wesentliche Aspekte und Schlüsselqualifikationen translationaler Forschung vermittelt werden. In den Jahren 2018-2022 wurden 18 Fellows und Projekte durch das CCCZ gefördert.
www.usz.ch/c3z-fellow-program
Die Universität Zürich und Medizinische Fakultät finanzierten das Programm mit CHF 4.9 Mio. für die Jahre 2018–2022.
Ida de Pottère-Leupold und Dr. iur. Erik de Pottère Krebsforschungspreis
Die Ida de Pottère-Leupold und Dr. iur. Erik de Pottère-Stiftung wurde 1960 von Dr. iur. Erik de Pottère gegründet, um die Krebsforschung an der Universität Zürich zu unterstützen. Seit 2019 verleiht das CCCZ den Ida de Pottère-Leupold und Dr. iur. Erik de Pottère Krebsforschungspreis, der alle zwei Jahre Doktoranden, Nachwuchswissenschaftler:innen und forschende Ärzt:innen des CCCZ auszeichnet, die einen bedeutenden Beitrag zur Grundlagen- oder klinischen Krebsforschung geleistet haben. Der Preis ist mit CHF 5.000 dotiert. Im Jahr 2023 wurden die Ida de Pottère-Leupold und Dr. iur. Erik de Pottère Krebsforschungspreise an Dr. Francisco Caiado (Klinik für Medizinische Onkologie und Hämatologie, USZ) und Dr. Annalisa Saltari (Klinik für Dermatologie, USZ) verliehen.
www.usz.ch/c3z-pottere-leupold-award
UP-DATE
Cancer Survivors Day – Mitten im Leben!
Am Samstag. 17. Juni 2023 fand der zweite Cancer Survivors Day unter dem Motto «Mitten im Leben» mit mehr als 400 Teilnehmenden statt. Das CCCZ lud Krebsbetroffen, sowie ihre Familien und Freunden ein, einen gemeinsamen Nachmittag im Lichthof der Universität Zürich zu verbringen. Das Programm umfasste Vorträge von CCCZ Expert:innen und Betroffenen sowie zahlreiche Workshops und Informationsstände zu Stressmanagement, Sport als Ressource, Yoga, Ernährung und Selbsthilfe. In der Panel-Diskussion unter dem Titel «Von der Diagnose über die Krankheit zurück ins Leben – Ein gemeinsamer Weg für Patient:innen, Angehörige, Freund:innen und Kolleg:innen» diskutierten Expert:innen und Krebsbetroffene über ihre Erfahrungen. Der Cancer Survivors Day 2023 «Mitten im Leben» war ein Fest der Begegnung, des Austauschs und der Fröhlichkeit. Es war eine Veranstaltung, die die Kraft, den Mut und den Optimismus der Krebsüberlebenden feierte und ihnen Raum bot, ihre Geschichten zu teilen und anderen Hoffnung zu geben.
www.usz.ch/veranstaltung/cancer-survivors-day-2023

UP-DATE
Patient Engagement
Durch den Austausch mit Selbsthilfegruppen und Patientenorganisationen möchten wir die Perspektive von Krebsbetroffenen besser verstehen und in den klinischen Alltag integrieren, um so die Versorgungsqualität am CCCZ stetig weiterzuentwickeln.
Durch die direkte Zusammenarbeit der CCCZ Organzentren mit Patientenorganisationen und Selbsthilfegruppen stellen wir sicher, dass Patient:innen am CCCZ über die Angebote der Patientenorganisationen strukturiert informiert werden. Im Jahr 2023 haben wir begonnen offizielle Kooperationsvereinbarungen mit Patientenorganisationen und Selbsthilfegruppen abzuschliessen, um die Zusammenarbeit weiter zu festigen.
Im Juli 2023 wurde der CCCZ Patientenbeirat gegründet. Mit Hilfe des Beirats soll die Sichtweise von Betroffenen und Angehörigen in die Planung und Durchführung von Prozessen und Entscheidungen am CCCZ einfliessen. Eine enge Zusammenarbeit besteht bereits bei der Organisation von Patientenveranstaltungen des CCCZ, wie dem Cancer Survivors Day und den Patient Academies, die Patientenorganisationen und Selbsthilfegruppen mitgestalten und durch eigene Beiträge bereichern. Zudem werden durch den gemeinsamen Austausch die Inhalte und Verständlichkeit der CCCZ Informationsmedien erarbeitet und verbessert. Mitglieder sind aktuell vier Vertreter:innen von Patientenorganisationen und Selbsthilfegruppen sowie mehr als 10 Vertreter:innen aus den CCCZ Kernbereichen Krebsmedizin und Krebsforschung.
Mitglieder von Patientenorganisationen und Selbsthilfegruppen im Patientenbeirat des CCCZ
Rosmarie Pfau, lymphome.ch, Patientennetz Schweiz
Michael Emmenegger, Verein Leben mit Lungenkrebs
Isabelle Nünninghoff, ElleHelp, Verein für gynäkologische Krebsarten
Christina Christen, Tavola Rosa Zürich, Europa Donna
UP-DATE
www.usz.ch/cccz/patient-engagement
#SOLAgegenKrebs 2023
Unter dem Dach der SOLA-Stafette lancierten das CCCZ und die UZH Foundation eine Awareness- und Spendenkampagne für Krebsbetroffene. Elf Laufteams mit über 150 Mitarbeitenden des CCCZ liefen mit und zeigten eine beeindruckende Leistung. Die 14-köpfigen Teams bewältigten jeweils eine Gesamtstrecke von 114.77 km und eine Höhendifferenz von 2.640 m rund um Zürich. Alles unter dem Motto #SOLAgegenKrebs.
Die SOLA-Stafette ist nicht nur ein Rennen, sondern auch eine Gelegenheit für die Mitarbeitenden des CCCZ ein Zeichen für die Gesundheit und den Kampf gegen Krebs zu setzen. Zudem sammelten die Teams Spenden für innovative Forschungsprojekte von Nachwuchsforschenden. Mit den Spendeneinnahmen werden junge Wissenschaftler:innen und Ärzt:innen am CCCZ durch Educational Travel Grants in ihrer akademischen Laufbahn unterstützt.

Das CCCZ bietet fachübergreifende diagnostische und therapeutische Konzepte nach höchsten medizinischen Standards. Die neusten Forschungsergebnisse beziehen wir stets mit ein. Wir stellen präzise Diagnosen und beraten individuell und ganzheitlich. Unser Behandlungsangebot umfasst moderne bildgebende und molekulare Diagnostik, Chirurgie, Strahlentherapie sowie zielgerichtete Systemund Immuntherapien.
An unseren 17 Organzentren stehen Patient:innen für die Abklärung, Beratung und Behandlung ein grosses Team aus Fachärzt:innen und onkologischen Fachpersonen zur Verfügung. An den wöchentlich stattfindenden Tumorboards besprechen sie gemeinsam die Diagnosen und Therapieempfehlungen für unsere Patient:innen. Unsere supportiven Beratungs- und Behandlungsdienste bieten eine physische, psychosoziale und seelische Unterstützung. All dies ermöglicht eine umfassende medizinische Betreuung, die einerseits die wirksamste Therapie gemäss den neusten wissenschaftlichen Daten anbietet und anderseits umfassend auf individuelle Bedürfnisse von Menschen mit Krebs eingeht. Das CCCZ ist nach den strengen Richtlinien der Deutschen Krebsgesellschaft als europäisches Comprehensive Cancer Center zertifiziert.
Auf einen Blick (Jahr 2023)
2.119 Primärfälle (DKG)
4.253 aktiv behandelte Patient:innen
17 spezialisierte Organzentren
20 wöchentlich stattfindende Tumorboards mit >9.000 Vorstellungen pro Jahr
15 supportive Beratungs- und Behandlungsdienste
1 zentrales online Zweitmeinungsportal

«Für gute Therapieentscheide braucht es gute Informationen. Wir gehen am CCCZ mit unseren Patient:innen die Extrameile und nutzen innovative Technologien, um die richtige Behandlung zum richtigen Menschen zu bringen. Diesen Weg gehen wir Schritt für Schritt gemeinsam, ohne die individuellen Bedürfnisse unserer Patient:innen aus den Augen zu verlieren.»
Andreas Wicki, Prof. Dr. med. Director CCCZ Clinical Program
CCCZ: Organzentren
Am CCCZ haben sich zahlreiche Fachbereiche zu spezialisierten Organzentren zusammengeschlossen und arbeiten interdisziplinär zusammen. So bündeln wir das Wissen von allen Expert:innen für die jeweiligen Tumorarten und Krebserkrankungen.
Das Angebot umfasst:
– Eine fundierte Erstabklärung und Diagnose durch moderne labordiagnostische und bildgebende Verfahren.
– Innovative und personalisierte Therapien nach höchsten medizinischen Standards und unter Einbezug der neuesten Forschungsergebnisse in den Bereichen Chirurgie, zielgerichtete System- und Immuntherapien, sowie Strahlentherapie.
– Behandlung in klinischen Studien nach Wunsch und Verfügbarkeit.
– Professionelle und kontinuierliche Begleitung und Beratung durch spezialisierte Pflegesprechstunden.
– Supportive Beratungs- und Behandlungsdienste für eine ganzheitliche, das heisst körperliche, psychosoziale und emotionale Unterstützung.
– Umfassende Nachsorgeuntersuchungen.

Blasen- und Nierentumorzentrum


Brustzentrum


Darmtumorzentrum


Endokrines und Neuroendokrines Tumorzentrum

Gynäkologisches Tumorzentrum


Hauttumorzentrum
Kopf-Hals-Tumorzentrum


Magen- und Ösophagustumorzentrum




Leber- und Pankreastumorzentrum
Hirntumorzentrum


Hoden- und Penistumorzentrum






Zentrum für Hämatologische Neoplasien
Lungen- und Thoraxonkologiezentrum



Prostatakarzinomzentrum

Sarkomzentrum


Schilddrüsentumorzentrum



CCCZ Organzentren: www.usz.ch/cccz-organzentren
Zentrum für Onkologie des UniversitätsKinderspitals Zürich

CCCZ: Tumorboards
Am CCCZ werden wöchentlich 20 interdisziplinäre Tumorboards durchgeführt mit >9.000 Vorstellungen pro Jahr.
Durch den interprofessionellen Austausch aller behandelten Fachabteilungen werden Diagnosen kritisch geprüft und die bestmögliche Therapiemöglichkeiten empfohlen. Durch die enge Zusammenarbeit aller Expert:innen ist ein optimaler Informationsfluss gewährleistet, welcher für die Planung der verschiedenen diagnostischen und therapeutischen Schritte wichtig ist. Ziel ist eine bestmögliche, auf wissenschaftlichen Kriterien basierende, qualitätsgesicherte und auf die individuellen Bedürfnisse jedes Menschen mit Krebs zugeschnittene medizinische Versorgung.
Alle Tumor Boards am CCCZ:
www.usz.ch/zuweisende/tumorboards
UP-DATE
CCCZ Molekulares Tumorboard
Am wöchentlichen, molekularen Tumorboard (MTB), an dem auch externe Kolleg:innen teilnehmen können, werden alle Patient:innen, bei denen eine Next-Generation-Sequencing (NGS)-basierte Tumoruntersuchung durchgeführt wurde, routinemässig vorgestellt. Zudem werden auch die Resultate aller Patient:innen besprochen, bei denen im Rahmen der Präzisionsonkologie-Programme des CCCZ (z.B. Swiss Personalized Oncology (SPO) oder Precision Oncology Program (POP)) weiterführende molekulare oder datenwissenschaftliche Abklärungen erfolgt sind. Zur Präsentation der molekularen und datenwissenschaftlichen Testergebnisse wurde eigens eine digitale Plattform (MTP-Software, Kahraman et al. JCO Clin Cancer Inform 2022) entwickelt. Anhand der klinisch-pathologischen, molekularen und datenwissenschaftlichen Ergebnisse werden personalisierte Therapieempfehlungen und Studienvorschläge formuliert. Im Jahr 2022 wurden >500 USZ-Patienten besprochen sowie >400 Patienten unserer Kollaborationspartner.
UP-DATE
Präzisionsonkologie & Therapie
Das CCCZ hat in Zusammenarbeit mit dem Tumor Profiler Center (siehe Kapitel 10.2) ein innovatives Präzisionsonkologie-Programm entwickelt. Dieses umfasst einen strukturierten Arbeitsablauf für ein molekulares Tumorprofiling: von Patientenaufnahme und Untersuchung, Patientenprobenverarbeitung, Pathologie, omics-Technologien, hochmodernen Datenverarbeitungstechnologien, molekularen Tumorboard-Auswertungen, Entwicklung klinischer Studien bis hin zur klinischen Anwendung. Die erkannten molekularen Eigenschaften von Tumoren geben immer häufiger Auskunft über die beste individuelle Therapie(kombination) gegen eine Krebserkrankung:
– Durch eine spezialisierte, robotergestützte oder minimalinvasive Tumorchirurgie können wir Tumore präzise und mit weniger Komplikationen entfernen.
– Modernste Bestrahlungsgeräte ermöglichen eine CT- oder sogar MR-basierte Millimeter-genaue Lokalisation von Tumoren und deren nicht-invasives radiotherapeutisches Abtöten. Diese ambulante Behandlung kann häufig bei sehr guter Verträglichkeit in den beruflichen und privaten Alltag integriert werden.
Zielgerichtete Systemtherapien richten sich gegen bestimmte biologische Eigenschaften eines Tumors. Die Medikamente wirken dadurch im Idealfall fast ausschliesslich auf das Tumorgewebe, verschonen die gesunden Zellen und haben weniger Nebenwirkungen.
– Immuntherapien versetzen die körpereigene Immunabwehr in die Lage, Tumorzellen zu erkennen und diese gezielt zu eliminieren.
UP-DATE
CCCZ Tagesklinikplattform
Am 26.4.2023 wurden die neuen Räumlichkeiten des CCCZ-Ambulatoriums mit über 2.000 Quadratmetern am USZ-Zentrum in Betrieb genommen. Es stehen insgesamt 30 Tages-Therapieplätze, 17 Untersuchungsund Behandlungsräume sowie eine Einheit zur Sammlung von Blutstamm- und Immunzellen zur Verfügung. Die Räumlichkeiten bieten Patient:innen nicht nur eine gebündelte medizinische Expertise, sondern auch eine angenehme Atmosphäre.


«Die interdisziplinäre Tagesklinikplattform mit einer koordinierten Versorgung schafft eine effiziente, patientenzentrierte Umgebung, die nicht nur die Patientenzufriedenheit und deren Wohlbefinden während einer Therapie verbessert, sondern auch zur Steigerung der Versorgungsqualität durch das medizinische Personal führt, indem Wissen und Erfahrung in einem spezialisierten Team ausgebaut und weitergegeben werden können.»
Anja Lorch, Prof. Dr. med. Leitende Ärztin und Stellvertretende Klinikdirektorin Onkologie, Medizinische Onkologie und Hämatologie, USZ

«In klinischen Studien möchten wir die rapiden Fortschritte der Präzisions-Radiotherapie für unsere Patient:innen verfügbar machen und lernen, wie wir die Therapie von morgen noch wirksamer und verträglicher gestalten können.»
Matthias Guckenberger, Prof. Dr. med. Klinikdirektor Radioonkologie, USZ
UP-DATE
Präzise Strahlenbehandlung dank MRI Linac
Das im Linearbeschleuniger integrierte MRT liefert qualitativ hochwertige Echtzeitbilder des Tumors, nicht nur vor, sondern auch während der Bestrahlung. Dadurch kann vor jeder Therapiesitzung die Bestrahlung an Änderungen der Tumorform und -grösse adaptiert werden. Zusätzlich werden auch Bewegungen des Tumors im Patienten während der Behandlung kontinuierlich erfasst und die Bestrahlung entsprechend angepasst.
Seit April 2019 haben wir als erste Strahlentherapie der Schweiz einen MR-Linearbeschleuniger in Betrieb. Der Vorteil dieses hoch-innovativen Geräts ist eine erhöhte Präzision der Bestrahlung. In der Folge wird eine verbesserte Verträglichkeit z.B. bei Kopf-Hals Tumoren, dem Prostata Karzinom und bestimmten Lungentumoren erwartet. Besonders grosse Vorteile erhoffen wir uns für Patient:innen mit Tumoren der Leber und im Oberbauch, die bisher nur eine sehr schlechte Prognose haben, sowie bei Patienten mit Prostatakarzinom. Wissenschaftlich untersuchen wir am MR-Linac, ob und wie die Bestrahlung nicht nur an anatomische, sondern auch an biologische Eigenschaften und Veränderungen des Tumors, angepasst werden kann: diese biologischen Tumoreigenschaften sollen mittels wiederholter Analyse der MR Bilder ermittelt werden, eine Technik die als Radiomics bezeichnet wird. Das MRIdian System bringt daher verschiedene Arbeitsgruppen aus dem USZ, der UZH und ETH zusammen, um den Zürcher Forschungsschwerpunkt der Bildgebung in der Krebsforschung weiter zu stärken.

UP-DATE
Zielgerichtete Immmuntherapie
In den letzten fünf Jahren wurde am CCCZ die gesamte klinische und regulatorische Infrastruktur zur Durchführung von CAR-T-Zell-Therapien aufgebaut und verfeinert, um zeitnahe, sichere und hochwertige Anwendungen zu gewährleisten. Mit der Apherese-Einheit und dem Zellaufbereitungslabor im Haus können wir zu kurzen Produktionszeiten beitragen. Patient:innen werden interdisziplinär durch die Kliniken für Medizinische Onkologie, Infektiologie, Neurologie, Kardiologie, Nephrologie, Geriatrie und Intensivmedizin betreut, um eine medizinische Versorgung auf höchstem Niveau zu gewährleisten.
Während kommerziell verfügbare CAR-T-Zellen von Pharmaunternehmen hergestellt werden, entwickeln wir am CCCZ zwei komplementäre, innovative klinische CAR-Immunzellplattformen der nächsten Generation. Die erste basiert auf der hocheffizienten mRNA-Elektroporation von nicht aktivierten, nicht expandierten peripheren mononukleären Blutzellen (PBMCs), die in unserem lokalen Zellverarbeitungslabor durchgeführt werden soll. Die zweite Strategie basiert auf nicht-viralen, an- und ausschaltbaren, multi-targeting Adaptor-CAR (Ad-CAR) T-Zellen unter Verwendung des Sleeping Beauty Transposon-Systems in Kombination mit kleinen Adapter-Molekülen, die unter GMP-Bedingungen hergestellt werden (siehe Kapitel 10.2).
Im Jahr 2023 wurden am CCCZ 29 kommerziell verfügbare CAR-T-Zell-Therapien zur Behandlung des grosszelligen B-Zell-Lymphoms, von indolenten Non-Hodgkin-Lymphomen und der akuten lymphoblastischen Leukämie durchgeführt.

«CAR-T-Zelltherapien eröffnen unseren Patient:innen neue kurative Optionen bei sonst fatalen bösartigen Erkrankungen.»
Dominik Schneidawind, Prof. Dr. med. Leitender Arzt, Medizinische Onkologie und Hämatologie, USZ

«Die an unserer Klinik seit einigen Jahren standardisiert eingesetzte, schonende Technik der minimalinvasiven Zugänge für Operationen an der Lunge und weiteren Tumoren im Brustraum ermöglichen –im Gegensatz zu den vormals offenen Verfahren – eine rasche Erholung unserer Patient:innen, was sich auch in einer Verkürzung der Hospitationszeit auf nur wenige Tage niederschlägt.»
Isabelle Schmitt Opitz, Prof. Dr. med.
Klinikdirektorin, Thoraxchirurgie, USZ
UP-DATE
Hochspezialisierte Thoraxchirurgie
Seit 2004 ist der DaVINCI Operations-Roboter in der Klinik für Thoraxchirurgie im Einsatz, seit 2016 werden damit zunehmend Lungen-Operationen durchgeführt. In den letzten Jahren konnten auch in fortgeschrittenen Stadien und komplexen Situationen, wie zum Beispiel nach Vorbehandlungen durch Chemo-Immunund /oder Radiotherapie, solche Eingriffe minimalinvasiv roboterassistiert oder konventionell thorakoskopisch durchgeführt werden. Die Patient:innen sind durchschnittlich nur noch vier Tage hospitalisiert und können somit baldmöglichst in ihre häusliche Umgebung zurückkehren, was die schonende Behandlung dieser minimal-invasiven Interventionen unterstreicht.


CCCZ: Pflegesprechstunden & Supportive Dienste
In Ergänzung zur ärztlichen Sprechstunde bieten wir unseren Patient:innen spezialisierte Pflegesprechstunden an. Zahlreiche supportive (unterstützende) Beratungs- und Behandlungsdienste ermöglichen eine ganzheitliche, das heisst körperliche, psychosoziale und emotionale, Betreuung. Unsere Expertenteams begleiten Patienten während ihrer Zeit an unserem Zentrum und bieten eine professionelle und kontinuierliche Unterstützung und Beratung. Hier gibt es Raum und Zeit für Austausch und individuelle Beratung im Zusammenhang mit pflegerischen und psychosozialen Themen. Pflegefachpersonen unterstützen beim Selbstmanagement und bei der Alltagsbewältigung im Rahmen der Erkrankung und Behandlung.
CCCZ Pflegesprechstunden

Palliative Care
Altersmedizinische Beratung
Psychoonkologie
Komplementärmedizin
Bewegung und Sport bei Krebs

Ernährungsberatung und -therapie
Genetische Beratung

Advance Care Planning und Patientenverfügung
Sozialberatung
Supportive Dienste: www.usz.ch/cccz-supportive-dienste

Raucher:innenberatung
Seelsorge

«Die Berücksichtigung individueller Bedürfnisse unserer Patient:innen ist wichtig für eine ganzheitliche Behandlung. In den Pflegesprechstunden erfassen wir den Unterstützungsbedarf frühzeitig und können so rasch und gezielt die Beschwerden von Patient:innen angehen. Durch die enge Abstimmung mit den supportiven Diensten und allen involvierten Fachbereichen können wir sicherstellen, dass unsere Patient:innen die bestmögliche Betreuung erhalten.»
Anna Götz, PhD CCCZ Pflegeexpertin
UP-DATE
Ein möglicher Patientenpfad am CCCZ
CCCZ Patientenpfade stellen sicher, dass allen Patient:innen professionelle Unterstützung zu allen Aspekten ihrer Krankheit zeitgerecht angeboten wird: So werden am CCCZ die interdisziplinären Behandlungsabläufe eng miteinander verzahnt. Dies umfasst die Aufnahme und Beratung in den spezialisierten Sprechstunden der Organzentren, die Entnahme von Tumorproben und diagnostischen Untersuchungen, die personalisierten Behandlungskonzepte der Tumorboards, die Prüfung auf Teilnahme in klinischen Studien, die Einbindung von supportive Beratungs- und Behandlungsdienste sowie die strukturierte Erfassung aller klinischen Daten und die Nachsorge. Lesen Sie hier mehr, zu einem möglichen Patientenpfad am CCCZ: www.usz.ch/praezisionsonkologie-am-usz

UP-DATE
DKG Zertifizierung: Behandlungsqualität nach höchsten Standards der Deutschen Krebsgesellschaft Das CCCZ wurde 2023 erneut nach den hohen fachlichen Anforderungen der Deutschen Krebsgesellschaft (DKG) zertifiziert. Damit erfüllt das CCCZ die anspruchsvollen Qualitätskriterien als Tumorzentrum (European Cancer Center) der DKG. Die 17 spezialisierten Organzentren des CCCZ haben die Re-Zertifizierung erfolgreich bestanden. Dies bedeutet für Krebsbetroffene fachübergreifende Diagnose- und Behandlungsmethoden nach höchsten medizinischen Standards.
Qualitätskriterien der Deutschen Krebsgesellschaft
Durch ihr Zertifizierungssystem möchte die DKG die Betreuung von Menschen mit Krebs verbessern. Krebsbetroffenen soll in jeder Phase ihrer Erkrankung eine Behandlung ermöglicht werden, die sich an strengen Qualitätskriterien orientiert. Dazu gehören unter anderem eine hohe Qualifikation von ärztlichem und pflegerischem Personal, eine grosse Anzahl an behandelten Patient:innen, eine fachübergreifende Abstimmung zu Diagnosen und Therapieempfehlungen in Tumorboards sowie die Behandlung nach Leitlinien und neusten wissenschaftlichen Erkenntnissen. Zudem müssen DKG-zertifizierte Zentren garantieren, dass Patient:innen bei Neudiagnose nicht länger als zwei Wochen auf einen Termin bei einem geeigneten Spezialisten warten müssen, wichtige Untersuchungen innerhalb von einer Woche nach der Diagnose stattfinden und Fachärzte aller Disziplinen jederzeit erreichbar sind. Die Zertifizierung erfolgt durch die DKG, da es aktuell kein Schweizer Zertifizierungsprogramm für die Qualitätssicherung an Tumorzentren gibt und die DKG-Kriterien international als hoher Standard anerkannt werden.
Das CCCZ als Vorreiter in der Schweiz Als zertifiziertes Zentrum muss das CCCZ jährlich nachweisen, dass es die fachlichen Anforderungen der DGK für die Behandlung von Tumorerkrankungen erfüllt. Die ersten Organzentren wurden am CCCZ bereits in 2011 zertifiziert. Seit 2013 ist das CCCZ mit über acht zertifizierten Organzentren als ein gesamthaftes Tumorzentrum (ein sog. onkologisches Zentrum) zertifiziert. Damit war das CCCZ Vorreiter in der Schweiz. Aktuell gibt es schweizweit 11 DKG-zertifizierte Tumorzentren. Über die Zertifizierung als Tumorzentrum hinaus erfüllt das CCCZ die Kriterien eines Comprehensive Cancer Center (CCC). An CCCs müssen Krebsmedizin und innovative Krebsforschung sowie die Weiterbildung für Expert:innen und Laien gebündelt werden. Am CCCZ arbeiten Ärzt:innen, Wissenschaftler:innen aus über 70 klinischen Abteilungen und Forschungsgruppen gemeinsam daran, wissenschaftliche Erkenntnisse in die klinische Anwendung zu übertragen. So können Patient:innen schnell vom wissenschaftlichen Fortschritt profitieren. Vorteile von zertifizierten Tumorzentren
Die Studie «Wirksamkeit der Versorgung in onkologischen Zentren (WiZen)» des Innovationsausschuss des Gemeinsamen Bundesausschuss (Berlin, Deutschland) untersuchte die Wirksamkeit der Gesundheitsversorgung an onkologischen Zentren bei folgenden Krebserkrankungen: Kolon-, Rektum-, Pankreas-, Mamma-, Zervix-, Endometrium-, Ovarial-, Bronchial- und Prostatakarzinom sowie Kopf-Hals- und neuroonkologischen Tumoren. Die Ergebnisse der Studie weisen darauf hin, dass Krebspatient:innen an zertifizierten Zentren im Durchschnitt eine bessere Überlebenschance haben. Quelle: WiZen Studie und Roesler M et al., BMC Cancer Vol. 22: 621, 2022.

«Die erneute Zertifizierung durch die Deutsche Krebsgesellschaft unterstützt uns in unserem Bestreben, unseren Patient:innen jederzeit die bestmögliche Abklärung und Behandlung von Krebserkrankungen anbieten zu können. Sie zeugt auch davon, dass es uns gelingt, sowohl umfassend und nach den neusten Standards für erkrankte Menschen zu sorgen als auch auf individuelle Bedürfnisse und Wünsche einzugehen.»
Andreas Wicki, Prof. Dr. med. Director CCCZ Clinical Program

9.3. CCCZ: Klinische Studien
Am CCCZ werden jährlich >190 klinische Studien durchgeführt. Patient:innen können so vom neusten Stand der Forschung und von innovativen Behandlungsmethoden profitieren.
Das im Oktober 2023 initiierte CCCZ Clinical Trial Program bildet den Grundstein für eine umfassende Strategie, die darauf abzielt, so vielen Patienten wie möglich einen Zugang zu klinischen Studien zu ermöglichen. Der Fokus des klinischen Studienprogramms liegt auf der Entwicklung innovativer Studien der Phase I und II sowie Investigator Initiated Trials. Dafür ist die Etablierung einer Early Clinical Trial Unit geplant. Unter dem Dach einer CCCZ Studienzentrale sollen administrative und operative Prozesse standardisiert und mit Hilfe einer Studienmanagementplattform digitalisiert werden. Zudem wird an der Entwicklung eines Zürcher Studiennetzwerks gearbeitet, um in Zusammenarbeit mit umliegenden Spitälern die Reichweite und den Umfang der klinischen Studien zu erweitern. Das CCCZ arbeitet bereits eng mit der SAKK (Schweizerische Arbeitsgemeinschaft für Klinische Krebsforschung) zusammen. In der Regel werden am USZ jährlich 40–80 Patient:innen in SAKK-Studien aufgenommen.
Auf einen Blick (Jahr 2023)
193 offene, klinische Studien an den CCCZ Organzentren
267 Patient:innen in therapeutischen Studien (Phase I–III) behandelt
UP-DATE
CCCZ Studienfinder
Der «CCCZ Studienfinder» ermöglicht es, alle onkologischen Studien der universitären Spitäler Zürich zu finden und bietet direkte Kontakte zu den verantwortlichen Studienteams:
www.krebsstudien-zuerich.ch

«Das CCCZ Clinical Trial Programm setzt sich dafür ein, die Teilnehmerrekrutierung mit harmonisierten Prozessen und moderner Digitalisierung weiterzuentwickeln. Die Schaffung eines zentralisierten Studienzentrums wird es uns ermöglichen, einem grösseren Patientenkreis Zugang zu neuen Behandlungsmöglichkeiten zu bieten.»
Alexandre Theocharides, Prof. Dr. med. CCCZ Director Clinical Trials
UP-DATE
Highlights Klinische Studien
Erkrankung: Hautkrebs
Studienakronym: CDYP688
Titel: Eine Phase-I/II-Studie mit DYP688 bei Patienten mit metastasiertem Aderhautmelanom und anderen GNAQ/11-mutierten Melanomen
Phase: Therapeutische Studie Phase I/II
Sponsor: Novartis
Kurzbeschreibung: Die innovative DYP688-Studie bietet neue Hoffnung für Patienten mit schwer behandelbarem metastasiertem uvealen Melanom. Dieses neu entwickelte Medikament zielt auf spezifische Mutationen in den GNAQ/11-Genen ab. Die Studie teilt sich in zwei Phasen: Die erste bestimmt die ideale Dosierung, während die zweite die Effektivität von DYP688 in einer grösseren Patientenpopulation untersucht. Ziel ist es, die Behandlungserfolge bei dieser aggressiven Melanomart signifikant zu verbessern.

«Durch die Mutation des GNAQ/11 Gens, die bei ca. 80% der Patient:innen mit Aderhautmelanom nachweisbar ist, werden Proteine namens GPCR produziert, die dazu führen, dass Melanomzellen wachsen und sich verbreiten. Das Antikörper-Wirkstoff-Konjugat DYP688 bindet zielgerichtet an ein Protein auf der Oberfläche von Melanomzellen und transportiert ein Krebsmedikament in die Zellen. Dadurch sollen die Wirkung von GPCR blockiert werden und die Krebszellen absterben. In dieser von uns entwickelten Studie wird DYP688 zum ersten Mal bei Patient:innen angewendet.»
Principal Investigator: Reinhard Dummer, Prof. Dr. med. Dermatologische Klinik, USZ
Erkrankung: Hirntumore
Studienakronym: GLUGLIO
Titel: Eine randomisierte, offene Phase-Ib/II-Studie zum Repurposing von Glutamat-Signalinhibitoren in Kombination mit Chemoradiotherapie bei Patienten mit neu diagnostiziertem Glioblastom
Phase: Therapeutische Studie Phase Ib/II
Sponsor: Universität Zürich
Kurzbeschreibung: Die GLUGLIO-Studie erforscht eine bahnbrechende Therapie für Patient:innen mit neu diagnostiziertem Glioblastom. Diese Phase Ib/II Studie vergleicht die Wirksamkeit einer zielgerichteten Kombination aus Standard-Chemoradiotherapie mit Temozolomid und den zusätzlichen antiglutamatergen Medikamenten, Gabapentin, Sulfasalazin und Memantin gegenüber der alleinigen Standard-Chemoradiotherapie. Ziel ist es, die Behandlungsergebnisse zu verbessern und neue Massstäbe in der Therapie dieses aggressiven Gehirntumors zu setzen.
UP-DATE

«Nervenzellen formen sogenannte Synapsen mit Glioblastomzellen, ähnlich den Verbindungen, über die Nervenzellen im gesunden Gehirn untereinander kommunizieren. Durch Ausschüttung des Neurotransmitters Glutamat werden auf den Glioblastomzellen Ionenkanäle aktiviert, die ein wachstumsförderndes elektrisches Signal hervorrufen. Die Dreifachbehandlung mit Gabapentin, Sulfasalazin und Memantin blockiert die Synthese, Ausschüttung und Signalwirkung von Glutamat. Diese bereits für andere Indikationen zugelassenen, gut verträglichen Medikamente werden im Rahmen der von uns initiierten Studie erstmals zur Behandlung des Glioblastoms untersucht.»
Principal Investigator: Hans-Georg Wirsching, PD Dr. med. Klinik für Neurologie, USZ
Erkrankung: Leukämie
Studienakronym: PHRT-RAPID-Studie
Titel: Pharmakoskopie (PCY)-geleitete klinische Standardbehandlung bei rezidivierter akuter myeloischer Leukämie (AML), eine randomisierte klinische Phase-2-Studie
Phase: Therapeutische Studie Phase II, IVD (In-vitro-Diagnostika)
Sponsor: ETH-Zürich in Kooperation mit dem Universitätsspital Zürich
Kurzbeschreibung: In der RAPID-01-Studie wird untersucht, wie die Pharmakoskopie, eine innovative Plattform für Präzisionsmedizin (Berend Snijder, ETH Zürich), die Auswahl der Standardtherapien für Patient:innen mit rezidivierter akuter myeloischer Leukämie (AML) optimieren kann. Diese Studie vergleicht direkt die Ergebnisse von herkömmlichen Therapieentscheidungen ohne Pharmakoskopie-Unterstützung mit solchen, die durch diese innovative Technologie geleitet sind, insbesondere im Hinblick auf die Erreichung einer Krankheitsremission. Diese Studie könnte einen bedeutenden Fortschritt in der Behandlung von AML markieren und die Basis für zukünftige Präzisionsmedizin-Strategien legen.

«Obwohl es mehrere Behandlungsoptionen für Patient:innen mit rezidivierender AML gibt, wurden keine von ihnen in einer randomisierten Studie verglichen, was die klinische Entscheidungsfindung erschwert. RAPID ist die prospektive, randomisierte klinische Studie, die Daten aus Arzneimittelscreenings in den Behandlungsentscheidungsprozess integriert, um die bestmögliche Behandlungsoption für Patient:innen mit rezidivierender/refraktärer AML zu identifizieren.»
Principal Investigator: Alexandre Theocharides, Prof. Dr. med. Klinik für Medizinische Onkologie und Hämatologie, USZ

Als integrativer Bestandteil des Departements für Pathologie und Molekularpathologie am USZ lagert die zentrale Gewebe-Biobank formalinfixierte, tiefgefrorene sowie organoide Gewebeproben maligner Tumoren zur Verwendung in Forschungsprojekten und klinischen Studien. Die Gewebeproben besitzen entsprechende Annotationen zu pathologisch-anatomischen Daten. Alle mit der Biobank verbundenen Prozesse, einschliesslich der Qualitätskontrolle der Gewebe, folgen standardisierten und akkreditierten Protokollen.
Aufgaben und Ziele:
– Pflege, Ausbau und professionelles Management der zentralisierten GewebeBiobank (Leitung: Dorothea Rutishauser).
– Viabilitätstests und Validierung der gelagerten lebenden Gewebe und Zellen.
– Unterstützung laufender und neuer Krebsforschungsprojekte unter Verwendung des Inventars der Gewebebiobank.
– Pflege und Erweiterung der Gewebebiobank-Datenbank.
– Beratung von Forschern in Bezug auf ethische und rechtliche Aspekte der Nutzung von Patientengewebe und -daten.
– Unterstützung des CCCZ Probenverarbeitungslabors.
– Aufrechterhaltung und Optimierung der Qualität der Biobankverfahren.
1 Zentralisierte Gewebe-Biobank, betrieben vom Institut für Pathologie, USZ
1 Zentrales Verarbeitungslabor für Tumorproben (C3Z Sample Processing Lab, CCCZ)
1.000 Lebendproben
1.200 Organoide (von 400 Patient:innen)
31.000 Frisch eingefrorenes Gewebe (von 17.000 Patient:innen)
100.000 FFPE-Proben
>100 Anfragen für Krebsforschungsprojekte/Jahr

«Die Gewebebiobank am USZ ist eine der wichtigsten Voraussetzungen für die translationale Forschung am CCCZ. Das Institut für Pathologie leistet damit einen grossen Beitrag für die Krebsforschung vieler Disziplinen.»
Holger Moch, Prof. Dr. med. CCCZ Director Translational Research Programs
UP-DATE
CCCZ Sample Processing Lab
Übergeordnetes Ziel des CCCZ ist die Etablierung von interdisziplinären Krebsforschungsprogrammen in der Präzisionsonkologie. Für die standardisierte Aufbereitung von Tumorproben wurde dafür am CCCZ im Jahr 2022 ein zentrales Probenverarbeitungslabor – das CCCZ Sample Processing Lab (CCCZ SPL) – etabliert. Das CCCZ SPL wird vom Institut für Pathologie und Molekularpathologie (Leitung CCCZ SPL Solide Tumore: Chantal Pauli, Prof. Dr. med.) und der Diagnostischen Hämatologie & Transfusionsmedizin der Klinik für Medizinische Onkologie und Hämatologie (Leitung CCCZ SPL Hämatologische Neoplasien: Thorsten Zenz, Prof. Dr. med.) am USZ betrieben. Die vorhandene Expertise garantiert eine qualitätsgesicherte Probenverarbeitung nach Standard Operating Procedures. Das Labor-Team berät und unterstützt CCCZ Forschungsgruppen bei der Prozessierung von Biomaterial für translationale Forschungsprojekte.

«Das CCCZ SPL hat das Know-how und ermöglicht unter anderem Projekte zur Etablierung von 3D Zellmodellen (Organoide) von soliden Tumoren. Mit Hilfe dieser Zellmodelle können wir zum Beispiel Medikamente testen und somit Therapieentscheide in der Klinik unterstützen.»
Chantal Pauli, Prof. Dr. med. Leiterin CCCZ SPL Solide Tumore, Institut für Pathologie und Molekulare Pathologie, USZ

In der Krebsforschung sind neue Technologien von entscheidender Bedeutung, um Fortschritte bei der Prävention, Diagnose und Behandlung von Krebserkrankungen zu erzielen. Neue Technologien ermöglichen es uns, die Effektivität von Krebstherapien zu erhöhen und die Lebensqualität der Patient:innen zu verbessern.
Die Forschungsgruppen am CCCZ entwickeln und nutzen neue Technologien vor allem im Bereich der Präzisionsonkologie. Ziel ist es, Patient:innen personalisierte Behandlungskonzepte anbieten zu können. Je nach Krebsart und Diagnose werden dabei unter anderem das Erbgut (Genomics), die Zusammensetzung von Proteinen (Proteomics), das Ansprechen auf Medikamente (Drug Pertubation) und die Interaktion mit dem Immunsystem (Immunoomics) bis auf die Ebene einzelner Zellen untersucht. Die erkannten molekularen Eigenschaften von Tumoren geben immer häufiger Auskunft über die beste individuelle Therapie einer Krebserkrankung. Unsere Tumoranalysen helfen zudem, die Biologie von Krebs besser zu verstehen. Damit können wir die Früherkennung von Krebs verbessern, neue personalisierte Therapien entwickeln und letztlich auch mehr Heilungserfolge bei guter Lebensqualität erreichen.
Auf einen Blick (Jahr 2023)
4 klinisch genutzte Arzneimittel-Screening-Plattformen
8 fakultätsübergreifende UZH-Technologieplattformen
27 innovative Technologieplattformen von CCCZ Forschungsgruppen
240 Patient:innen, die mittels multiautomatischer Einzelzell-Profilierung des Tumor Profiler Center (TPC) analysiert wurden
>400 Patient:innen, die bis Ende 2025 ein TPC-Profiling erhalten werden
www.research.uzh.ch/de/infrastructure/platforms.html

«Die neuesten Technologien erlauben es, die Kommunikation der Tumorzellen untereinander und mit ihrer Umgebung zu verstehen und für Therapien zu nutzen.»
Bernd Bodenmiller, Prof. Dr. rer. nat. CCCZ Director Technologies
Tumor Profiler Center
Im Tumor Profiler Center (TPC) bündeln über hundert Kliniker:innen und Forschende ihre Kräfte und untersuchen die Eigenschaften von bösartigen Tumoren von Krebspatient:innen auf zellulärer Ebene. Ziel ist es, für jeden Tumor die Mechanismen der Krebsentwicklung zu verstehen und vorherzusagen, welche Krebstherapie für die Patient:innen am erfolgversprechendsten ist. Dafür werden verschiedene wissenschaftliche Analyseverfahren – sogenannte Omics-Technologien – kombiniert, um die Gesamtheit der genetischen, biochemischen und zellulären Veränderungen sowie die Reaktion der Tumorzellen auf Krebsmedikamente zu erfassen. Die dabei anfallenden grossen Datenmengen werden unter Verwendung von maschinellem Lernen und künstlicher Intelligenz bioinformatisch ausgewertet. Die Ergebnisse werden in einem «Molekularen Tumorboard», bestehend aus Forschenden und Onkolog:innen, diskutiert und in einen auf den einzelnen Patienten bzw. die einzelne Patientin zugeschnittenen Therapievorschlag umgesetzt. Das Ganze geschieht in einer klinisch relevanten Zeit von vier Wochen, damit die Patient:innen schnellstmöglich von der Therapie profitieren können. Lesen Sie mehr in Kapitel 10.2.
Das Tumor Profiler Center ist ein Konsortium der Universität Zürich, der ETH Zürich und den Universitätsspitälern Zürich und Basel.
www.tumorprofilercenter.ch

Die Verarbeitung grosser Mengen an genetischen, klinischen und bildgebenden Daten mithilfe von künstlicher Intelligenz ermöglicht eine genauere Analyse von Krebsinformationen. Dies trägt dazu bei, Muster und Zusammenhänge zu identifizieren, die für die Krebsentstehung und -behandlung relevant sind. Das Bioinformatikprogramm des CCCZ umfasst drei prioritäre Ziele: (1) Konsolidierung der Krebsdaten des CCCZ, (2) Aufbau einer digitalen Patient-Reported Outcome Measure (PROM)-Infrastruktur, um Krebspatient:innen unter Therapie zu begleiten und (3) Aufbau einer Community und Expertise für computergestützte Krebsmodellierung.
Ziel ist der Aufbau von Prozessen und (digitalen) Werkzeugen zur Sammlung von Krebsdaten, die es ermöglichen, mithilfe der künstlichen Intelligenz «aus Daten zu lernen». Um die Grundlage für ein digitales Krebszentrum zu schaffen, werden aktuell verschiedene Datenprojekte vorangetrieben: Unterstützung der strukturierten Berichterstattung (Radiologie, Pathologie, Onkologie); Entwicklung von Werkzeugen zur Strukturierung von Onkologie-Textdaten; Aufbau einer integrierten Datenbank, die alle krebsbezogenen Daten zusammenführt und ganzheitliche Analysen über klinische und Omics-Variablen ermöglicht; Aufbau einer robusten PROMInfrastruktur (s.u.), welche es ermöglicht, die integrierte Datenbank mit patientenzentrierte Daten anzureichern. Das CCCZ hilft auch bei der Vernetzung und Aufbau einer Bioinformatics Community, um CCCZ Daten effizient auf den vorhandenen Computer-Infrastrukturen zu verarbeiten und zu modellieren.
3 UZH High Performance Computing Infrastrukturen über S3IT www.zi.uzh.ch/en/teaching-and-research/science-it/computing.html
4 USZ IT Systeme für die onkologische Forschung und Daten Reporting (SecuTrial, REDcap, CentraXX, Onkostar)
16.000 Patientendatensätze in der onkologischen/CCCZ Kohorte, wobei kontinuierlich an der Datenvervollständigung (z.B. Diagnosen, Krebsstadium, Therapie und Verlauf) gearbeitet wird.


«Wir ermöglichen den Zugang zu Krebsdaten, um aus historischen Patientenverläufen zu lernen und durch KI Algorithmen verbesserte Krebstherapien zu entwickeln.»
Michael Krauthammer, Prof. Dr. med. CCCZ Director Bioinformatics
UP-DATE
DIZH Projekt – Ein Praxislabor für patientenzentrierte Klinische Innovation
Im Januar 2023 wurde das Projekt Digital Health Zurich zur Implementierung einer PROM-Infrastruktur am CCCZ gestartet. Diese erfasst Daten zu Gesundheit, Symptomen und Lebensqualität aus der Perspektive von Patient:innen und ermöglicht es, ihre eigenen Einschätzungen und Erfahrungen in die medizinische Bewertung einzubeziehen. Das Projektziel ist die Entwicklung einer digitalen PROM-Plattform, auf der innovative mobile Technologien für die Erfassung und Analyse von Patientendaten erforscht werden können.
Das Projekt ist in der frühen Implementierungsphase und arbeitet mit Patient:innen aber auch Fachpersonen in der Ausgestaltung einer App. Die Grundidee ist es, die vom Krebs oder von der Therapie verursachten Symptome elektronisch zu erfassen und daraus über einen Algorithmus abzuleiten, welche supportiven Dienste des CCCZ am besten helfen können. Der Entscheidungsweg wird am Anfang über einfache Regeln gehen und im Verlauf durch die Anwendung künstlicher Intelligenz verbessert werden. Damit das funktionieren kann, braucht es Informationen über die Art der Erkrankung, die Art der Therapie und die über die Zeit hinweg wahrgenommenen Symptome unserer Patienten. Eine elektronische Erfassung und eine Verknüpfung mit den supportiven Diensten des CCCZ, wie z.B. der Ernährungsberatung oder der Psychoonkologie, kann uns dabei helfen, rascher und gezielter die Beschwerden von Patient:innen mit Krebserkrankungen anzugehen und damit hoffentlich die Belastung durch die Erkrankung zu reduzieren.
Das Projekt setzt auch einen starken Fokus auf die Forschung. Ein Ziel ist die Implementierung im Spitalkontext - wir haben den Anspruch, den Behandlungsverlauf von Patienten des CCCZ und später anderen Kliniken positiv zu beeinflussen. Um dies zu messen, werden wir spezifisch erfassen, ob die App die Bedürfnisse von Patient:innen gut abbildet und diese zu den korrekten supportiven Services leitet. Sekundär interessiert es uns, ob wir mit Sensoren die manuelle Eingabe von Symptomen teilweise ersetzen können.
Das Projekt wird durch die Digitalisierungsinitiative der Zürcher Hochschulen DIZH finanziert.
PIs: Michael Krauthammer, Andreas Wicki
www.dizh.uzh.ch/2022/07/07/zurich-applied-digital-health-center

Mediziner:innen und Wissenschaftler:innen aus rund 70 klinischen Abteilungen und Forschungsgruppen der UZH, des USZ, des KiSpi, des Balgrist und der ETHZ arbeiten gemeinsam daran, die Entstehung und Entwicklung von Krebs besser zu verstehen und innovative Behandlungskonzepte zu entwickeln.
Wissenschaftliche Schwerpunkte bilden die interdisziplinären Forschungsbereiche für Tumorimmunologie, (Epi)Genetik und Genomik, Onkogene Signalwege sowie Bildgebung, Technologieentwicklung und Digitalisierung. Eine Schlüsselaufgabe besteht darin, eine kontinuierliche Verbindung von der Grundlagenforschung bis zu klinischen Studien zu schaffen. So können wissenschaftliche Entdeckungen effektiv in personalisierte Therapien und Diagnoseverfahren umgesetzt werden.
Erfahren Sie mehr zu unseren Forschungsbereichen:
www.usz.ch/cccz-krebsforschung
Auf einen Blick (Jahr 2023)
4 wissenschaftliche Fokusbereiche am CCCZ: Tumorimmunologie, (Epi-)Genetik und Genomik, onkogene Signalübertragung, sowie Bildgebung, Technologieentwicklung und Digitalisierung
>70 Krebsforschungsgruppen
229 begutachtete Krebsforschungsprojekte, gefördert mit CHF 37,8 Mio. Drittmitteln (2022)
>600 Publikationen mit CCCZ-Mitgliedern

«Zürich hat mit seinen beiden renommierten Hochschulen und der Spitzenmedizin seiner vier universitären Kliniken die besten Voraussetzungen, eine weltweite Vorbildfunktion einzunehmen: wie Erkenntnisse der Grundlagenforschung gewonnen und weiterentwickelt werden können, dass sie den Krebspatient:innen in naher Zukunft als vorteilhafte Therapien dienen.»
Konrad Basler, Prof. Dr. rer. nat. CCCZ Director Basic Research
UP-DATE
CCCZ Leuchtturmprojekte
Die UMZH fördert aktuell vier Leuchtturmprojekte am CCCZ mit insgesamt CHF 6 Mio. von 2022-2026. Ziel dieser interdisziplinären, translationalen Krebsforschungsprogramme ist es, die Grundlagenforschung mit der klinischen Forschung zu verbinden, so dass Patient:innen rasch von neuen wissenschaftlichen Fortschritten profitieren können. Die Projekte wurden im Rahmen eines kompetitiven Bewerbungsverfahren durch ein internationales Expertengremium ausgewählt.




Cancer Microbiome – Darmbakterien gegen Krebs
Leiter: Michael Scharl, Prof. Dr. med., Klinik für Gastroenterologie, USZ
Aktuelle Studien zeigen, dass die Zusammensetzung der Milliarden von Bakterien in unserem Mikrobiom im Darm direkte Folgen für die Wirksamkeit gewisser Therapien hat. Diese Erkenntnisse aus dem Innenleben des Darms werden im CCCZ Leuchtturmprojekt «Cancer-Microbiome» durch ein interdisziplinäres Team untersucht. Ziel ist es, die massgebenden Bakterien und molekularen Mechanismen zu entschlüsseln und die Ansprechraten auf eine Immuntherapie zu erhöhen.
Leiterin: Chiara Magnani, Prof. Dr. med., Klinik für Medizinische Onkologie und Hämatologie, USZ
IMMUNO-CAR ZURICH (ZURICAR) zielt darauf ab, innerhalb des CCCZ innovative Plattformen für die effektive, flexible, sichere und kosteneffiziente Produktion von Chimeric Antigen Receptor (CAR)-Immunzellen zu entwickeln. Dies sind genetisch manipulierte körpereigenen Immunzellen, die gezielt an Krebszellen andocken und diese zerstören. Die Zellprodukte werden im Wyss Zentrum Zurich hergestellt und sollen in klinischen Phase-I-Studien bei Patient:innen mit dringendem Bedarf für effektive Therapien eingesetzt werden.
DISEASE PROGRAM – OMD ZH
Leiter: Matthias Guckenberger, Prof. Dr. med., Klinik für Radioonkologie, USZ
Oligometastasierung beschreibt einen Zustand der begrenzten Metastasierung von soliden Tumoren, bei welchem durch die Kombination einer medikamentösen Therapie zusammen mit einer lokalen Therapie aller sichtbaren Tumorherde eine Chance auf Langzeitüberleben oder sogar Heilung besteht. OMDZH zielt darauf ab, das klinische und biologische Verständnis oligometastatischer Erkrankungen zu verbessern und kombinierte Behandlungsstrategien zu entwickeln, die einerseits ein frühzeitiges molekulares Ansprechen berücksichtigen, und die gleichzeitig die individuelle Lebensqualität in die Patientenentscheidung einbinden.
Präzisionsonkologie zur Verbesserung der Überlebenschancen von Krebspatient:innen mit ZNS-Metastasen (PROMIS)
Leiterin: Emilie Le Rhun, PD Dr. med., Klinik für Medizinische Onkologie und Hämatologie, USZ
Metastasen des zentralen Nervensystems (ZNS) stellen eine zunehmende Herausforderung dar, aufgrund ihrer steigenden Prävalenz und ihrer negativen Auswirkung auf die Lebensqualität und das Überleben. Das PROMIS Projekt setzt sich zum Ziel, das Überleben von Krebserkrankten mit ZNS-Metastasen zu verbessern. Dazu sollen mit Hilfe von modernsten molekularen Analysen Schwachstellen von Hirnmetastasen aufgedeckt und die Wechselwirkung mit dem Gehirngewebe genauer untersucht werden. Die neu gewonnenen Erkenntnisse sollen für die Entwicklung gezielter therapeutischer Ansätze genutzt werden.
Erfahren Sie mehr zu den CCCZ Leuchtturmprojekte im Kapitel 10.2. und hier: www.usz.ch/c3z-translationale-krebsforschung

CCCZ integrates and supports cancer research activities of the UZH, USZ, the Balgrist University Hospital, the University Children’s Hospital Zurich and ETHZ. The overall aim is to develop novel diagnostic and therapeutic concepts towards precision oncology.
As an interdisciplinary research platform, CCCZ enables cutting edge research on the molecular and cellular mechanisms of cancer, the establishment of novel technologies and the development of innovative clinical trials. Scientists and physicians from around 70 research groups and clinical departments work closely together to facilitate the translation of scientific discoveries into clinical applications.
Within this unique environment, CCCZ aims to:
Integrate the knowledge and expertise of all cancer experts in Zurich.
Facilitate the translation of scientific discoveries into clinical applications.
Develop interdisciplinary cancer research programs in precision oncology.
Establish and apply novel technologies in translational and clinical concepts.
4 CCCZ focus research areas: Tumor Immunology, (Epi)Genetics & Genomics, Oncogenic Signaling, and Imaging, Technology Development & Digitalization
10 specifically funded interdisciplinary cancer research networks
>70 cancer research groups
229 active, cancer-related, peer-reviewed grants with CHF 37.8 Mio. third-party funding (2022)
>600 cancer-related publications with CCCZ members
At CCCZ, dedicated research areas have been established for Tumor Immunology, (Epi)Genetics & Genomics, Oncogenic Signaling and Imaging, Technology Development, and Digitalization.




Research studies show that the immune system can influence the development and progression of cancer. Strengthening the immune system is therefore a promising therapeutic approach to fight cancer. Physicians and scientists of the CCCZ Research Area Tumor Immunology investigate the interaction between the tumor and immune system. The overall aim is to develop novel and targeted immunotherapies with minimal side effects.
Many of the characteristics of cancer cells, such as malignant growth and the ability to metastasize, are influenced by genetic changes. Research groups of the CCCZ Research Area Epigenetics, Genetics and Genomics study gene and genome alterations in cancer cells aiming to develop novel treatment concepts that selectively target cancer cells.
Signal transduction pathways within and between cells are often deregulated in cancer and contribute to uncontrolled growth and metastasis. Investigators of the CCCZ Research Area Oncogenic Signaling aim to gain a better understanding of the complex networks of signaling pathways that regulate various cellular processes and how they are dysregulated in cancer cells. A key focus is exploring the effect of cancer drugs at the molecular level and strategies to overcome drug resistance.
The CCCZ Research Area for Imaging, Technology Development and Digitization pursues the goal of developing personalized diagnosis and treatment methods against cancer. Novel imaging techniques, such as innovative MRI sequences, PET imaging and radiomics, enable precise characterization of tumors. High-throughput molecular technologies, like sequencing, proteomics, metabolomics and imaging, are essential for molecular diagnostics and monitoring of disease progression. For the analysis of scientific and clinical data, the development of modern bioinformatics and information technologies are of central importance.
www.usz.ch/c3z-research-areas
UP-DATE
Metastasis-directed radiotherapy in combination with targeted therapy or immunotherapy: systematic review and consensus recommendations by the EORTC-ESTRO OligoCare consortium Lancet Oncol. 2023;24(3):e121-e132.
Kroeze SGC, Pavic M, Stellamans K, …, Matthias Guckenberger
Stereotactic body radiotherapy (SBRT) for patients with metastatic cancer, especially when characterized by a low tumor burden (i.e., oligometastatic disease), receiving targeted therapy or immunotherapy has become a frequently practiced and guideline-supported treatment strategy. Despite the increasing use in routine clinical practice, there is little information on the safety of combining SBRT with modern targeted therapy or immunotherapy and a paucity of high-level evidence to guide clinical management. A systematic literature review was performed to identify the toxicity profiles of combined metastases-directed SBRT and targeted therapy or immunotherapy. These results served as the basis for an international Delphi consensus process among 28 interdisciplinary experts who are members of the European Society for Radiotherapy and Oncology (ESTRO) and the European Organisation for Research and Treatment of Cancer (EORTC) OligoCare consortium. Consensus was sought about risk mitigation strategies of metastases-directed SBRT combined with targeted therapy or immunotherapy; a potential need for and length of interruption to targeted therapy or immunotherapy around SBRT delivery; and potential adaptations of radiation dose and fractionation. Results of this systematic review and consensus process compile the best available evidence for safe combination of metastases-directed SBRT and targeted therapy or immunotherapy for patients with metastatic or oligometastatic cancer and aim to guide today›s clinical practice and the design of future clinical trials.

«With this study, we were able to demonstrate how state-of-the-art radiation therapy and state-of-the-art drug therapy can be optimally combined.»
Matthias
Guckenberger
Radiation Oncology, USZ

In Zurich, 10 interdisciplinary cancer research networks – in the fields of Molecular Diagnostics/Targeted Therapy, Immuno-oncology, Metastasis, and the Cancer Microbiome – aim to:
Connect the basic research environment with oncological patient care.
Translate scientific findings into clinical practice. Patients must rapidly benefit from new scientific progress. Develop novel diagnostic and therapeutic concepts towards precision oncology.




UP-DATE
CCCZ Lighthouse Projects
Tumor Profiler Center
The LOOP Zurich – INTeRCePT: Intercept clonal evolution to overcome treatment resistance in childhood and adult blood cancer
UZH CRPP – Precision Hematology/Oncology
UZH CRPP – Artificial Intelligence in oncological imaging
CCCZ Lighthouse Project: IMMUNO-CAR ZURICH
UZH CRPP – ImmunoCure: Targeted Cancer Immunotherapy
HMZ Research Program – ImmunoTarget
CCCZ Lighthouse Project: PROMIS – Precision oncology to improve survival in patients with CNS metastasis
CCCZ Lighthouse Project: OMDZH – The CCCZ oligometastatic disease program
CCCZ Lighthouse Project – Cancer Microbiome
In 2021, we have established the competitive CCCZ Precision Oncology Funding Program aiming to foster outstanding translational cancer research projects. Within the frame of two competitive, externally peerreviewed CCCZ calls in 2021 und 2022, four CCCZ Lighthouse Projects are funded with a total sum of CHF 1.6–2 Mio. each for 3.5. years. The CCCZ Lighthouse Projects:
Meet the mission of CCCZ as a Comprehensive Cancer Center of Excellence. Encompass innovative translation of scientific findings into clinical practice. Patients must rapidly benefit from new scientific progress.
Address an unmet clinical need.
Aim to strengthen the research interface at CCCZ connecting the basic research environment with oncological patient care.
Aim to combine innovative clinical oncology, research, and technologies to develop novel diagnostic and therapeutic concepts towards precision oncology

Lead PIs
Andreas Wicki (Medical Oncology and Hematology, USZ/UZH), Bernd Bodenmiller (Quantitative Biomedicine, UZH/ ETH), Viola Heinzelmann (University Hospital Basel)
Keywords
Oncology, Precision Medicine, Therapy Prediction, Functional and Multi-Omics Testing
The Tumor Profiler Center (TPC) is a cancer-specific research consortium and competence hub of the universities (UZH, ETH) and university hospitals in Zurich and Basel.
State-of-the-art single-cell analysis platforms are used to assess tens of thousands of biomarkers from solid or liquid patient samples within the time-frame of two weeks. The generated data are used to generate a clinical report. This report is used for support of therapy decisions at the molecular board (fast diagnostic loop). All data are mined through machine-based learning and artificial intelligence for diagnostic, prognostic and predictive information (exploratory loop). TPC includes cohorts of patients with specific diagnoses. In the current funding period (2023–2026), this includes ovarian cancer, melanoma, colorectal cancer, lung cancer and breast cancer. These cohorts are run as two separate HFV projects (OvPredict project and SPO NDS project) and under a specific informed consent. All patients from the University Hospital Zurich participating in TPC cohorts are also discussed at the regular molecular tumor board. From 2018 to 2021, 240 patients with melanoma, ovarian cancer and acute myeloid leukemia (AML) were included and analyzed by TPC.

Several tens of thousands of biomarkers can be assessed from each tumor sample within two weeks. They contain information on the vulnerabilities of a tumor and can be mined for information on potential drug targets and best treatment strategy.
Scientific Achievement
We performed long-read single-cell RNA sequencing (scRNA-seq) on clinical samples from three ovarian cancer patients presenting with omental metastasis and increase the PacBio sequencing depth to 12,000 reads per cell. Our approach captures 152,000 isoforms, of which over 52,000 were not previously reported. Isoform-level analysis accounting for non-coding isoforms reveals 20% overestimation of protein-coding gene expression on average. With these findings, we envision long-read scRNA-seq to become increasingly relevant in oncology and personalized medicine.

Study design
a) Schematic of freshly processed HGSOC omentum metastases and patient-matched tumor-free distal omentum tissue biopsies, scRNA-seq. b) Definition of SQANTI-defined isoform structural categories. c) Proportions of isoform structural categories detected in merged metastasis and distal omentum samples. Percentage and total number of isoforms per category are indicated. d) Proportions of unique reads attributed to isoforms detected in (c). Percentage and total number of UMIs per category are indicated.
Selected Publication
Detection of isoforms and genomic alterations by high-throughput full-length single-cell RNA sequencing in ovarian cancer. Arthur Dondi , Ulrike Lischetti, Francis Jacob, Franziska Singer, Nico Borgsmüller, Ricardo Coelho; Tumor Profiler Consortium; Viola Heinzelmann-Schwarz, Christian Beisel, Niko Beerenwinkel. Nat Commun. 2023 Nov 27;14(1):7780
Lead PIs
Thorsten Zenz (Medical Oncology and Hematology, USZ/UZH), Burkhard Becher (Experimental Immunology, UZH), Nico Beerenwinkel (Biosystems Science and Engineering, ETHZ), Jean-Pierre Bourquin (Oncology, KiSpi/UZH), Wolfgang Huber (Quantitative Biology and Statistics, EMBL), Andreas Moor (Biosystems Science and Engineering, ETHZ), Berend Snijder (Molecular Systems Biology, ETHZ)
Funding
CHF 5 Mio., 2021–2026, The LOOP Zurich
Keywords
Blood Cancer, Treatment Resistance, Molecular Profiling
Precision medicine for blood cancer patients: We investigate the biomolecular reactions in ultra-high resolution at the level of individual cells. This will help us understand the heterogeneity of tumor and normal immune cells, and their interactions.
Patients with lymphoma or acute lymphoblastic leukemia who do not respond to treatment have a bleak outcome. Over 1100 patients die with leukemia and lymphoma in Switzerland annually, despite a diverse treatment landscape. There is a major need to optimize treatment selection for patients with blood cancer. To improve the outcome of lymphoid malignancies in children and adults, we will channel relapsing blood cancer patients in Zurich into a new Innovation Clinic.
Treatments are applied, often multiple times consecutively, and each time tumors and normal blood cells are collected before treatment. In laboratory experiments, we determine the precise molecular state as well as the dynamic response of these collected tumor samples, at multiple levels of their molecular biology and at single-cell resolution. The drugs will include all drugs potentially available for treatment, including those used in the patient. By computational analysis, we construct a detailed single-cell map of drug response and use this to derive a broadly applicable procedure aimed at extinction of the tumor (INTeRCePT), which we test in a trial, aiming to increase response rate by 50%.

«Drug perturbation of primary tumor samples allows us to measure and understand the fingerprint of medication we use to ultimately improve the selection of drugs for individual patients.»
Thorsten Zenz Medical Oncology and Hematology, USZ/UZH
Selected Publication
Ex vivo drug response profiling for response and outcome prediction in hematologic malignancies: the prospective non-interventional SMARTrial. Liebers N, Bruch PM, Terzer T, Hernandez-Hernandez M, Paramasivam N, Fitzgerald D, Altmann H, Roider T, Kolb C, Knoll M, Lenze A, Platzbecker U, Röllig C, Baldus C, Serve H, Bornhäuser M, Hübschmann D, Müller-Tidow C, Stölzel F, Huber W, Benner A, Zenz T, Lu J, Dietrich S. Nat Cancer. 2023 Dec;4(12):1648-1659
Lead PIs
Jean-Pierre Bourquin (Oncology, KiSpi), Thorsten Zenz (Medical Oncology and Hematology, USZ/UZH)
Funding
CHF 1.8 Mio., 2020–2023, UZH
Keywords Precision Medicine, Drug Response Screening
The CRPP “Precision Hematology/Oncology” joins forces to develop a clinical platform for next-generation precision medicine. We aim to apply drug response profiling to personalize treatment of patients and investigate unexpected vulnerabilities at depth. Despite rapid progress in cancer genomics and molecular disease classification, it remains difficult to identify actionable targets and predict response to drugs based on this information. New approaches that identify cancer vulnerabilities and predict the response to treatment based on pre-treatment testing of individual cancer cells could improve response rates, reduce unnecessary treatments, and significantly increase cost-effectiveness. Based on strong proof-of-concept data, the CRPP hypothesizes that critical predictive and mechanistic information can be obtained from direct functional drug response screening of primary patient samples.

«The CCRP Precision Hematology/Oncology enables a long-haul cluster of excellence within CCCZ and UMZH to develop a new generation of precision medicine assays with concrete translation into clinical practice.»
Jean-Pierre Bourquin Oncology, KiSpi
Selected Publication
Subgroup-specific gene expression profiles and mixed epistasis in chronic lymphocytic leukemia. Almut Lütge, Junyan Lu, Jennifer Hüllein, Tatjana Walther, Leopold Sellner, Bian Wu, Richard Rosenquist, Christopher C Oakes, Sascha Dietrich, Wolfgang Huber, Thorsten Zenz. Haematologica. 2023 Oct 1;108(10):2664-2676
Lead PIs
Jürg Hodler (Radiology, USZ), Matthias Guckenberger (Radiation Oncology, USZ)
Funding
CHF 1.8 Mio., 2020–2023, UZH
Keywords
Oncological Imaging, Artificial Intelligence, Machine Learning
We aim to develop applications of artificial intelligence (AI) in oncological imaging. Improvements are expected in two directions. First, AI techniques facilitate automation and standardization of labor-intensive routine tasks of physicians. Second, AI algorithms allow for quantitative analysis of medical images and facilitate detection of image features not perceivable to the human eye.
The CRPP combines competences of physicians and scientists from USZ, UZH, and ETH Zürich to explore the potential of AI in oncological imaging. The network exploits interdisciplinary synergies between clinical disciplines, translational research, and theoretical laboratories in the application of AI techniques. As knowledge of these methodologies is recognized as a core competence for the next generation of scientist and medical doctors, a strong emphasis is put on developing an educational curriculum for the young scientists who are supported and mentored by this program.
Specific aims of the network are:
– Build a powerful network of AI research at USZ, UZH, and ETHZ.
– Promote state-of-the-art AI research for interdisciplinary oncological research projects.
– Accelerate translation from theoretical to clinical science.
– Build a common AI platform compatible with the clinical environment.
– Foster young scientists in the development of AI competencies.

«Artificial intelligence will significantly influence the future of medicine, particularly if we manage to integrate the expertise and data from the various areas of medical imaging.»
Matthias Guckenberger Radiation Oncology, USZ
Selected Publication
Saliency-Enhanced Content-Based Image Retrieval for Diagnosis Support in Dermatology Consultation: Reader Study. Gassner M, Barranco Garcia J, Tanadini-Lang S, Bertoldo F, Fröhlich F, Guckenberger M, Haueis S, Pelzer C, Reyes M, Schmithausen P, Simic D, Staeger R, Verardi F, Andratschke N, Adelmann A, Braun RP. JMIR Dermatol. 2023 Aug 24;6:e42129

Lead PIs
Chiara F Magnani (Medical Oncology and Hematology, USZ), Tobias Weiss (Neurology, USZ), Markus G Manz (Medical Oncology and Hematology, USZ), Bernd Bodenmiller (Quantitative Biomedicine, UZH)
Funding
CHF 2 Mio., 2023–2026, CCCZ
Keywords
Cancer immunotherapy, Chimeric antigen receptor (CAR), Non-viral gene transfer
The central aim of this project is to establish innovative platforms for the production of potent, safe, and costeffective CAR immune cells that will subsequently be translated in patients with unmet medical needs and evaluated through precision medicine and single-cell monitoring approaches.
CAR T-cell immunotherapy is a new perspective of precision medicine which use gene transfer technology to generate T cells with improved anti-tumor activity. Despite their success in B-cell neoplasms, efficacy of CAR T-cell therapy is still limited in myeloid and solid tumors due to immunosuppressive tumor microenvironments, heterogeneous diseases, and poor tumor infiltration. Furthermore, most CAR T-cell therapies depend on viral vectors, which are associated with logistical complexity and high costs. The goal of the project is to establish and apply two complementary, innovative next-generation clinical CAR immune cell platforms which rely on virus-free technology. The first platform is based on highly efficient mRNA electroporation into peripheral blood mononuclear cells (PBMCs). This platform will be applied within a phase I clinical trial in patients with refractory glioblastoma by intratumorally administration. The second platform relies on Sleeping Beauty (SB) Adaptor (Ad)-CAR T cells, and leverages stable, cost-efficient gene transfer of a switchable, multi-targeting CAR T cells in combination with small adaptor molecules. This will be accompanied by research on CAR immune-monitoring and efficacy improvement.

«ZURICAR aims to develop and apply in the clinic innovative concepts of advanced medicine using gene therapy and cell transfer of CAR immune cells with increased efficacy, and safety for individuals with late-stage cancers who have limited other treatment options. Through the tight collaboration of scientists, doctors, and physician-scientists, this project will facilitate the establishment of a platform for cell therapies in Zurich and increase their applicability in oncology.»
Chiara F. Magnani Medical Oncology and Hematology, USZ

Scientific Achievement/Prelimnary Work
Schematic representation of the first study using donor-derived anti-CD19 CAR T cells generated with Sleeping Beauty (SB) transposon in B-cell acute lymphoblastic leukemia (B-ALL) patients relapsed after HSCT, demonstrating that non-viral vectors and donor cells can be used to achieve treatment of patients with fulminant relapse.
Selected Publication
Sleeping Beauty-engineered CAR T cells achieve anti-leukemic activity without severe toxicities. Magnani CF, Gaipa G, Lussana F, Belotti D, Gritti G, Napolitano S, Matera G, Cabiati B, Buracchi C, Borleri G, Fazio G, Zaninelli S, eTettamanti S, Cesana S, Colombo V, Quaroni M, Cazzaniga G, Rovelli A, Biagi E, Galimberti S, Calabria A, Benedicenti F, Montini E, Ferrari S, Introna M, Balduzzi A, Valsecchi MG, Dastoli G, Rambaldi A, Biondi A. J Clin Invest. 2020 Nov 2;130(11):6021-6033
Lead PIs
Felix Beuschlein (Endocrinology, Diabetology and Clinical Nutrition, USZ), Markus Manz (Medical Oncology and Hematology, USZ)
Funding
CHF 1.0 Mio., 2020-2023, HMZ
Keywords
Immmunotherapy, Autoimmunity, Neuroendokrine Tumors
ImmunoTargET aims to transform pathologic mechanisms of autoimmunity into efficient tools to fight cancer of endocrine organs.
Autoimmune diseases and cancer have highly interesting parallels that can be used for novel therapeutic approaches. Tumors that originate from endocrine (hormone-producing) organs, such as the thyroid gland, the parathyroid gland, the pituitary gland or the gastrointestinal tract, are often characterized by excessive hormone production and frequently retain the functional and molecular properties of their originating organ. Of the much more common autoimmune diseases against endocrine organs (e.g. type 1 diabetes, autoimmune thyroiditis), it is known that the body’s own antibodies often completely destroy hormone-producing cells. This principle is used to attack endocrine tumors with specific immunotherapies. Immuno-TargET aims to isolate and characterize autoimmune effectors and antibodies and transform them in anti-cancer agents via the generation of multispecific T-cell activators and CAR immune effecor cells such as CAR T-cells.

«We are privileged to gather a strong team of researchers and clinicians from different disciplines including immunology, oncology and endocrinology to provide innovative means against endocrine tumors.»
Felix Beuschlein
Endocrinology, Diabetology and Clinical Nutrition, USZ
Selected Publication
Metastatic Pheochromocytoma and Paraganglioma: Somatostatin Receptor 2 Expression, Genetics, and Therapeutic Responses. Fischer A, Kloos S, Maccio U, Friemel J, Remde H, Fassnacht M, Pamporaki C, Eisenhofer G, Timmers HJLM, Robledo M, Fliedner SMJ, Wang K, Maurer J, Reul A, Zitzmann K, Bechmann N, Žygienė G, Richter S, Hantel C, Vetter D, Lehmann K, Mohr H, Pellegata NS, Ullrich M, Pietzsch J, Ziegler CG, Bornstein SR, Kroiss M, Reincke M, Pacak K, Grossman AB, Beuschlein F, Nölting S J Clin Endocrinol Metab. 2023 Sep 18;108(10):2676-2685
IMMUNOCURE
Lead PIs
JPatrick Roth (Neurology, USZ), Markus Manz (Medical Oncology and Hematology, USZ)
Funding
CHF 3 Mio., 2019–2024, UZH
Keywords
Engineered Immunotherapy, T-cell Engagers and Activators, Car-T Cells and NK-Cells
ImmunoCure focusses on novel, “engineered” immunotherapeutic concepts such as T cell engaging and activating bispecific antibodies (TEA) as well as CAR-T cell and CAR-NK cell therapy.
Immunotherapy represents a key promising area of novel therapeutic approaches against cancer. The CRPP ImmunoCure aims at establishing and expanding the concepts of T cell engaging and activating antibodies and CAR-T cells as cornerstones of a “targeted therapy development and technology immunotherapeutic platform” in Zurich that includes (i) monoclonal antibody engineering, (ii) CAR cell engineering, (iii) in vivo modeling and 3D imaging of (CAR) T cell traveling and target cell killing; and (iv) profiling of immune cell responses. ImmunoCure explores these technologies in two “targeted therapy lead disease focus programs”, one on brain tumors and one on hematologic stem cell malignancies as acute myeloid leukemia and myelodysplastic syndromes.

«ImmunoCure establishes an innovative immunotherapeutic platform, utilizing advanced technologies like T cell engaging antibodies and CAR-T cells, to develop novel therapeutic options for patients with brain tumors and hematologic stem cell malignancies.»
Patrick Roth Neurology, USZ
Selected Publication
Targeted delivery of tumor necrosis factor in combination with CCNU induces a T cell-dependent regression of glioblastoma. Look T, Puca E, Bühler M, Kirschenbaum D, De Luca R, Stucchi R, Ravazza D, Di Nitto C, Roth P, Katzenelenbogen Y, Weiner A, Rindlisbacher L, Becher B, Amit I, Weller M, Neri D, Hemmerle T, Weiss T. Sci Transl Med. 2023 May 24;15(697)

Lead PIs
Matthias Guckenberger (Radiation Oncology, USZ), Isabelle Schmitt-Opitz (Thoracic Surgery, USZ), Burkhard Becher (Institute of Experimental Immunology, UZH), Nikola Biller-Andorno (Institute of Biomedical Ethics and History of Medicine, UZH)
Funding
CHF 2 Mio., 2023–2026, CCCZ
Keywords
Oligometastatic Disease, Radiomics, Liquid Biopsy, Immunophenotyping, Decision Support System
It is the aim of the OMDZH research proposal to advance the rapidly evolving field of oligometastatic cancer by a deeper clinical and especially biological disease characterization and thereby improve patient selection and the design of personalized treatment strategies. Specifically, we aim to improve the precision of oligometastatic patient selection for a combined modality treatment strategy with curative intent and to personalize maintenance systemic therapy by early molecular response assessment and quality-of-life centric patient decision support systems.
Until today, few biomarkers aiding the identification of patients with a true oligometastatic state have been proposed and they all suffer from low discriminative power and lack of validation. This CCCZ flagship project OMDZH aims to advance our clinical and biological under-standing of oligometastatic disease and thereby improve patient selection and the design of personalized treatment strategies. Specifically, we aim to improve imaging- and tissue-based identification of oligometastatic cancer patients, who achieve a long-term survival benefit of definitive local therapy. Additionally, we aim to improve early response assessment by liquid-biopsy and develop a patient decision support system based on patient reported outcomes measures (PROMS) for designing a personalized systemic treatment strategy.

«We formed a multi-disciplinary and multi-professional project team to address the unique challenges of oligometastatic cancer patients. We are therefore convinced that OMDZH represents high-impact and relevance, clinically for many cancer patients and scientifically for CCCZ, making this a unique opportunity to become a true lighthouse project with national and international recognition.»
Matthias Guckenberger
Radiation Oncology, USZ

Systematic review with total number of SBRT-treated metastases per targeted agent group and anatomical location of SBRT-treated metastases.
Scientific Achievement/Prelimnary Work
Results of this systematic review and consensus process compile the best available evidence for safe combination of metastases-directed SBRT and targeted therapy or immunotherapy for patients with metastatic or oligometastatic cancer and aim to guide today’s clinical practice and the design of future clinical trials.
In the body group, location was not further specified. 0–10% of toxicity is defined as low risk, 11–20% of toxicity is defined as intermediate risk, and >20% of toxicity is defined as increased risk. SBRT=stereotactic body radiotherapy.
Selected Publication
Metastases-directed stereotactic body radiotherapy in combination with targeted therapy or immunotherapy: systematic review and consensus recommendations by the EORTC-ESTRO OligoCare consortium. Kroeze SGC, Pavic M, Stellamans K, Lievens Y, Becherini C, Scorsetti M, Alongi F, Ricardi U, Jereczek-Fossa BA, Westhoff P, But-Hadzic J, Widder J, Geets X, Bral S, Lambrecht M, Billiet C, Sirak I, Ramella S, Giovanni Battista I, Benavente S, Zapatero A, Romero F, Zilli T, Khanfir K, Hemmatazad H, de Bari B, Klass DN, Adnan S, Peulen H, Salinas Ramos J, Strijbos M, Popat S, Ost P, Guckenberger MA. Lancet Oncol. 2023 Mar;24(3):e121-e132
Lead PI
Emilie Le Rhun (Medical Oncology and Hematology, USZ)
Funding
CHF 150K, 2022–2025, CCCZ. PROMIS is additionally supported by Sophien Foundation, Stiftung für angewandte Krebsforschung (SAKF), Promedica
Keywords
Brain, Cancer, Metastasis
PROMIS aims to improve the survival of cancer patients with CNS metastases. To this end, state-of-the-art molecular analyses is used to uncover weak points of brain metastases and to study their interaction with brain tissue in more detail. The newly gained knowledge will be used for the development of targeted therapeutic approaches.
Unbiased approaches have indicated that the changes found in brain metastases may be rather heterogeneous. These considerations support the major prediction of this project that tissue acquisition from brain metastases followed by deep molecular profiling may disclose vulnerabilities specific to brain metastases that may be amenable to targeted interventions. Moreover, deciphering the host response in the brain as opposed to metastases outside the CNS may disclose new avenues on how to best treat CNS metastasis. Preclinical studies aim at understanding the interaction of the tumor cells and the micro-environment. Towards translational research, liquid biopsies (blood and cerebrospinal fluid) in CNS metastases are conducted. Drug testing using pharmacoscopy in brain metastases is performed in collaboration with ETH (Prof. B. Snijder). Based on encouraging results, a clinical trial (Evidence, see figure below) aiming at demonstrating a clinical benefit of pharmacoscopy selected drugs for a personalized approach is planned at several sites in Switzerland.

«To address the challenges of one of the most important research areas in oncology, CCCZ in 2018 defined CNS Metastasis as one of the top priority projects of the Zurich cancer research network. It builds on the excellence and cooperative efforts of multiple clinical and experimental research groups at the Zurich University Hospitals, UZH and ETH. Our annual Zurich Brain Mets Symposium provides state-of-the-art presentations on current and future diagnostic and therapeutic approaches for patients with brain and leptomeningeal metastasis.»
Emilie Le Rhun Medical Oncology and Hematology, USZ

Ex Vivo Drug response Evaluation for Next generation Care of Brain Metastases: EViDENCE-BM
Clinical Trial Highlights
IT-IO: Intrathecal administration of anti-PD1/anti-CTLA-4 in combination with systemic combination of anti-PD1/ anti-CTLA-4 in patients with NSCLC without oncogenic driver mutation or melanoma and newly diagnosed leptomeningeal metastasis: a multicentric phase I study.
This trial is a phase I trial conducted at several sites in Switzerland to explore the safety and preliminary activity of intrathecal double immune checkpoint inhibition in patients with newly diagnosed brain metastasis from nonsmall cell lung cancer or melanoma. The recommended phase II dose has now been established and the expansion phase is ongoing. The trial is supported by a grant from Bristol Myers Squibb.
ETOP 19-21 USZ-STRIKE: Immunotherapy or targeted therapy with or without stereotactic radiosurgery for patients with brain metastases from melanoma or non-small cell lung cancer. This trial is conducted under the sponsorship of ETOP and examines whether patients with newly diagnosed brain metastasis from non-small cell lung cancer or melanoma, who are candidates for systemic treatment, should receive radiosurgery upfront or at further progression. The trial was made possible by the USZ foundation.
Selected Publications
Stratification of radiosensitive brain metastases based on an actionable S100A9/RAGE resistance mechanism. Monteiro C, ……, Le Rhun E, Weller M, Soffietti R, Bertero L, Ricardi U, Bosch-Barrera J, Sais E, Teixidor E, Hernández-Martínez A, Calvo A, Aristu J, Martin SM, Gonzalez A, Adler O, Erez N; RENACER; Valiente M. Nat Med. 2022 Apr;28(4):752-765
Leptomeningeal metastasis from solid tumours: EANO-ESMO Clinical Practice Guideline for diagnosis, treatment and follow-up. Le Rhun E, Weller M, van den Bent M, Brandsma D, Furtner J, Rudà R, Schadendorf D, Seoane J, Tonn JC, Wesseling P, Wick W, Minniti G, Peters S, Curigliano G, Preusser M; EANO Guidelines Committee and ESMO Guidelines Committee. Electronic address: clinicalguidelines@esmo.org. ESMO Open. 2023 Oct;8(5):10162

CCCZ LIGHTHOUSE PROJECT: CANCER-MICROBIOME – UNRAVEL THE PO-
ACH
Lead PIs
Michael Scharl (Gastroenterology, USZ), Mitch Levesque (Dermatology, USZ), Anne Müller (IMCR, UZH), Ralph Fritsch (Medical Oncology and Hematology, USZ)
Funding
CHF 1.6 Mio., 2022–2025, CCCZ
Keywords
Cancer, Microbiome, Immunotherapy, Precision Oncology
The microbiome has the potential to revolutionize cancer care by providing treatment alternatives for patients who do previously not respond to cancer (immuno-)therapy (CI). In our project, a prospective interventional fecal microbiota transplantation (FMT) trial and extensive downstream molecular sample analysis will contribute to the understanding of the microbiome-host interactions and enable the identification of new targets to be validated and translated into a further refined interventional precision oncology FMT trial. Our recent efforts in Zürich have enabled us to leverage the microbiome as a biomarker and therapeutic target, as well as to combine high-resolution multi-omics platforms and medical bioinformatics to optimize patient care towards precision oncology. Our interventional clinical trials will provide immediate translation into clinical practice, and thus directly benefit cancer patients. Our project connects basic and translational research environments with oncologic patient care and invests in the interdisciplinary combination of computational power, detailed clinical patient characterization, and high-resolution multi-omics data in a clinical setting. Our aim is to unlock the potential of the microbiome as a therapeutic target, overcome existing limitations in cancer therapy, and establish a new therapeutic concept to foster precision oncology.

«The need for treatment alternatives for patients with refractory malignant diseases is high and our complementary and synergistic research approach explores the power of the microbiome as a promising solution. This interdisciplinary project combines clinical trials with experimental cancer model systems performed by members of the Comprehensive Cancer Center at the University Hospital Zurich and the University of Zurich.»
Michael Scharl Gastroenterology and Hepatology, USZ


Left: Tumor volume curve (mm 3) in the single strains prophylactic approach during the course of the experiment performed by Montalban et al. Right: Representative tumors from single strains prophylactic experiment.
Scientific Achievement/Prelimnary Work
This paper demonstrates the ultimate goal of our CCCZ project: identifying specific bacteria that, based on human data, have the potential to serve as anti-tumor therapy. The two single-strain bacteria identified in this paper are now pursued to be used as stand-alone cancer therapy in lyophilized form in a pH-resistant capsule in colorectal cancer patients. Within the CCCZ project, we finally aim to identify specific bacteria or bacterial metabolites that could serve as specific therapeutic agents.
Selected Publications
Commensal Clostridiales strains mediate effective anti-cancer immune response against solid tumors. Montalban-Arques A, Katkeviciute E, Busenhart P, Bircher A, Wirbel J, Zeller G, Morsy Y, Borsig L, Glaus Garzon JF, Müller A, Arnold IC, Artola-Boran M, Krauthammer M, Sintsova A, Zamboni N, Leventhal GE, Berchtold L, de Wouters T, Rogler G, Baebler K, Schwarzfischer M, Hering L, Olivares-Rivas I, Atrott K, Gottier C, Lang S, Boyman O, Fritsch R, Manz MG, Spalinger MR, Scharl M . Cell Host Microbe. 2021 Oct 13;29(10):1573-1588.e7

YEAR 2022 – PUBLICATIONS OF ALL CCCZ MEMBERS
YEAR 2023 – PUBLICATIONS OF ALL CCCZ MEMBERS
Möchten Sie die Entwicklung neuer Diagnosemethoden und Therapien gegen Krebs fördern?
Gemeinsam mit Ihnen als Gönner:in unterstützt die USZ Foundation medizinische und wissenschaftliche Initiativen am Comprehensive Cancer Center Zürich, damit Patient:innen so bald wie möglich davon profitieren können.
All unsere Projekte helfen mit, die Behandlung von Krebsbetroffenen weiter zu verbessern.
Wir freuen uns, wenn Sie uns unterstützen! Sie können auch direkt mit uns Kontakt aufnehmen. Gemeinsam finden wir ein Vorhaben, das Ihnen besonders am Herzen liegt.
Kontakte
USZ Foundation
+41 43 254 55 00 info@usz-foundation.com www.usz-foundation.com
CCCZ Geschäftsführung
+41 44 635 37 24 cccz@usz.ch
Unsere Bankverbindung – vielen Dank für Ihre Spende!
USZ Foundation
Zürcher Kantonalbank
Kontonummer IBAN: CH23 0070 0110 0065 6961 9
Spendenzweck: Comprehensive Cancer Center Zürich
Comprehensive Cancer Center Zürich (CCCZ)
Rämistrasse 100
8091 Zürich
www.www.usz.ch/fachbereich/comprehensive-cancer-center-zuerich
Folgen Sie dem USZ unter